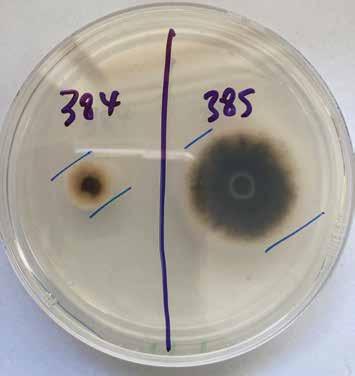

![]()


GREYSTONE is a large-fruited, grey-skinned pumpkin.
This variety is a great option for processors as it produces high yields of fruit between 3-6kg. The deep shoulder and minimal skin ribbing, in conjunction with a small seed cavity, assist high recoveries.
The flesh colour is a very dark orange, a defining feature of GREYSTONE. This variety has the advantage of very little pink skin discolouration during storage and will hold well after harvest.
GREYSTONE is a variety that sets fruit close to the crown and along the runners. It can be planted at a slightly higher density than fully-vining grey varieties, further increasing the yield potential.

Trial seed is now available. Contact us today if you would like to add GREYSTONE to your trial program.
MERCURY has a more blocky fruit shape and larger fruit size than other current market-standard grey pumpkin varieties.

MERCURY is an attractive pumpkin with a light-grey skin, well suited to shop displays for this reason. It is not commonly affected by sunburn, or pinking during storage.
With a bigger fruit, excellent internal flesh colour and a small seed cavity, MERCURY is a strong fit for the cut pumpkin market.
A semi-bush type plant, MERCURY is a reliable producer of high yields of quality fruit.





A regular advertorial section of new products and services. This publication does not endorse the products or services featured here.
64 Farmlands Horticulture Building Back Better
Grower Mark De Costa at his orchard. See page 10.
Photo by Kristine Walsh.
It’s wonderful to see the days getting longer and the colours and green shoots starting to come back as spring arrives. Hopefully, we’re saying goodbye to winter. And a note to the weather gods, no major frosts in spring please!
By Barry O’Neil : HortNZ president
I hope that most of us will see good crops being set in spring, positioning us well for a bountiful harvest.
We also have an important new beginning at Horticulture New Zealand, with the announcement of our new chief executive Kate Scott.
On behalf of HortNZ, I’d like to warmly welcome and congratulate Kate.
The calibre of candidates for the chief executive role was exceptional, however Kate stood out for her energy and ability to not only deliver on our strategy and priorities, but also look for opportunities for wider collaboration.
We look forward to Kate starting with us on 17 October. Hopefully many of you know Kate already, or met her at our conference and Annual General Meeting.

I am sure Kate will confidently navigate the sector’s complexities, demonstrating the courage to unpick and fully understand key issues while remaining focused on delivering results that will make a difference for growers and the wider horticulture industry.
She has an impressive background, which includes having jointly founded Landpro 17 years ago and being a Nuffield Scholar. She chairs the NZ Rural Leadership Trust and was last year named the Rabobank Australasian Emerging Leader.
She has been working in agribusiness for 20 years, proving herself to be a strong and effective leader, a collaborative relationship builder, a thought leader and practical problem solver.
Kate’s whakapapa is to Ngāi Tahu, and she is also experienced in leading organisations and people, fostering a strong sense of team and enabling those she works with to succeed.
Michelle Sands, HortNZ general manager strategy and policy, is standing in as interim chief executive until Kate starts.
I also want to congratulate Dean Smith on being appointed the chief executive of Summerfruit NZ and Karen Morrish on being confirmed as the chief executive for NZ Apples & Pears.
It’s fantastic to have such great people in leadership roles in the horticulture sector. Our sector needs to get in behind and support our leaders to deliver what our growers want, which is less patch protection, less duplication and more collaboration.
Kate stood out for her energy and ability to not only deliver on our strategy and priorities, but also look for opportunities for wider collaboration
Of course, with new beginnings there is often a goodbye. We said goodbye to our chief executive Nadine Tunley at our conference in Mount Maunganui.

A WARM WELCOME TO KATE SCOTT, WHO IS HORTICULTURE NEW ZEALAND’S NEW CHIEF EXECUTIVE.
Nadine has been amazing in the role, always connected, always looking for the best horticulture and organisational outcomes, and always encouraging us to find a better way of working.
Nadine led us through some really tough times, including Covid-19, a labour crisis as a result of closed borders, as well as Cyclone Gabrielle, and achieved some incredible results horticulture-wide.
She has joined Scales Corporation as its chief risk officer, and we wish her all the best for the next stage of her career.
Kia kaha.
Another successful winter season is coming to a close!
As the last trees leave the nursery, we’re closing out the season with a renewed sense of resilience and optimism for the year ahead. A big shout out to our incredible staff and a heartfelt thanks to our loyal customers and horticulture partners for your continued support. We’re excited for what 2025 will bring— there are exciting developments on the horizon, and we can’t wait to share them with you all!

& Kia ora koutou.
NZGrower & Orchardist is produced by Horticulture New Zealand and is free for all levy payers. The magazine is partially funded by a grant from the NZ Fruitgrowers’ Charitable Trust to ensure all fruit growers in New Zealand receive a copy each month. The magazine is also supported by Vegetables NZ, Process Vegetables NZ, TomatoesNZ, Potatoes NZ and Onions NZ.
The individual comments and views in this magazine do not necessarily represent the view of Horticulture New Zealand.
NZGrower including vegetable growing section:
ISSN: 2230-2700 (Print)
ISSN: 2744-5712 (Online)
The Orchardist including fruit growing section:
ISSN: 1173-3802 (Print)
ISSN: 2744-5992 (Online)
Acting Editor: John Gauldie, editor@hortnz.co.nz
Advertising Managers:
• Debbie Pascoe, 027 485 8562 debbie.pascoe@hortnz.co.nz
• Jackie Enright, 0274 489 913 jackie.enright@hortnz.co.nz
Design:
Scenario.co.nz, 04 385 9766, joy@scenario.co.nz
Subscriptions: subs@hortnz.co.nz
This publication uses vegetable-based inks and environmentally responsible paper produced from Forest Stewardship Council® (FSC®) certified, Mixed Source pulp from Responsible Sources.
Paper produced using Elemental Chlorine Free (ECF) and manufactured under the strict ISO14001 Environmental Management System.
The wrapper we use is 100 percent recyclable, it is LDPE 4 (Low Density Polyethylene) Soft Plastic and meets the required standards. For further information refer to: www.recycling.kiwi.nz/our-story
Welcome to our spring issue! This month Horticulture New Zealand brings together our tandem titles for growers – NZGrower & Orchardist – into one title. For the next three months we will trial this format and gather your feedback.
As you will have noticed, our June, July and August issues featured the head-to-tail publication of both titles. Thank you to those who shared their feedback. The head-to-tail approach highlighted the value of stronger connections among fruit and vegetable growers – creating opportunities to accelerate innovation, investment and growth across horticulture.
This spring issue is the next step. The NZGrower & Orchardist shares horticulture-wide grower stories and best practice. However, you will also find a crop-specific section in the centre of the magazine that relates to your business.
We thank our advertisers for their continued support of the grower community while we work through these changes. We are also grateful for the ongoing support from the NZ Fruitgrowers’ Charitable Trust and the vegetable product groups.
Together with your feedback we will decide a sustainable direction for the future. Please contact me to share your thoughts on this issue. Meanwhile we wish you a productive start to the busy spring season!
Kate Longman
HortNZ general manager engagement kate.longman@hortnz.co.nz 029 770 9874



















Being elected as the president of the Pukekohe Vegetable Growers’ Association (PVGA) earlier in the year was an especially memorable occasion for Simon Wilcox.
Glenys Christian
Attending the organisation’s Annual General Meeting were his grandfather, Alan, who turned 100 last September, and his father, Garth. Both are life members of the PVGA and have represented Pukekohe growers at a national level in the past.
“It was pretty special,” he says.
“I wouldn’t be where I am today without them, and they should be recognised for their service to the industry.”
And while the older Wilcoxes generally don’t give him advice, “they’ll tell me if I’m on the wrong track”.
Simon, who is in his mid-40s, was very much born into growing, as a third-generation grower. Alan grew vegetables with his brother Graham before he went dairy farming, then with his sons Garth and Rob (who died in 2013), trading as
Wilcox Brothers. Simon went to Lincoln University to gain a Diploma in Horticultural Management, working in the third practical year for a Prebbleton grower as well as a packhouse in Hornby.
“That really opened my eyes more to arable production,” he says.
He returned home and joined his father, Garth, to form Pinnacle Growers. They cropped around 120 hectares at Bombay with balanced areas of new season potatoes, onions for both the domestic and export market, as well as crown pumpkin and butternut pumpkin.
“We had quite a presence in the market due to branding with stickers of both pumpkins and butternuts,” he says.
“Consumers really started recognising our Pinnacle brand.”
Getting one more serving of vegetables on consumers’ plates is one answer to the current oversupply situation says new Pukekohe Vegetable Growers’ Association president, Simon Wilcox. And he’s all for using the power of social media to promote that.
“We need to be brave to participate in that space,” he says.
“While growers are generally conservative, they can share a positive story. And while some growers are doing that very well, we could do more.”
The benefits of greater vegetable consumption could also be promoted through linkages with government agencies, demonstrating the potential reduction this could bring in health conditions and the burden they are placing on the country’s health system.
On 1 March this year, vegetables.co.nz launched Add One More Vegetable. The aim of this initiative is, as the name suggests, to encourage people to Add One More Vegetable to as many meals as they can.
The initiative is being run in partnership with 5+ A Day. To date, activity has included radio advertising and promotion, social media, interviews with spokespeople, in-store promotion, and the development of lesson

But trialling small pumpkins called pumpkinos they struggled to establish this new product and any further work was halted. After a few more years they could clearly see that the scale of their business meant it wasn’t sustainable, so they made the hard decision to close it down.
They had existing relationships with A S Wilcox, the company that handled their new season potatoes and export onions, and Simon found work there as potato crop supervisor in charge of field operations and technical issues.
“I was coached by Monty Spencer and that developed my skill set,” he says.
Sometimes the vegetable sector doesn’t get the recognition of the export opportunities there could be
“The planning was a lot more detailed than I was used to, with a 52-week sales programme. And I was exposed to more technical elements of growing with for example, agronomists visiting from the United Kingdom.”
In 2011 Simon became production manager for Pukekohe, taking the lead in carrots, onions, potatoes and other rotational crops, overseeing 12 full-time workers, with
numbers increasing almost to 30 in the summer harvesting period. With a number of nationalities represented he says the cultural mix left him with a better understanding of people.
Five years later he became operations manager – growing, supporting the company in the areas of people, land, processes and equipment. Then in September last year he became general manager of operations, moving more into the post-harvest area, quality and food safety, assets, engineering and transport. Again it was a steep learning curve stepping up to manage 150 workers, understanding more about people and their behaviour as well as alignment to business goals and objectives.
“There were challenges during Covid-19, but our people were amazing coming together to deliver fresh food to New Zealanders,” he says.
“They really went above and beyond.”
And that extended to some staff who, because of medical condition or age, were not required to be essential workers.
“They were still fighting to come to work.”
Those difficult days brought about some positive changes in company processes, particularly in the use of technology.
“We found that with better communication we didn’t need so many face-to-face meetings,” Simon says.

And he’s “immensely proud” of recent innovations such as the introduction of the Beta Bites snacking carrots, putting snack-sized vegetables firmly in front of children. Simon is married to Steph and they have two children, Hamish (10) and Emily (8), who happily choose these vegetable options rather than lollies when they’re offered.
Simon joined the PVGA in 2002, seeing it as a great opportunity to meet other growers, understand their issues and to work with different people.
“All my life I’d seen that through the involvement of my grandfather and father,” he says.
“It’s more about giving than taking, and making growing a better industry. Most people view it that way and it’s a common theme for the Wilcox family.”
Asked about the greatest change he’s seen during the time of his involvement he says that when he first joined, discussions often were to do with pricing and market conditions.
“Now the conversations are all around the environment and sustainability,” he says.
“In those days we didn’t even know what that meant. But practices such as silt mitigation are second nature now.”
Simon was a board member of LandWISE for ten years, and says its small annual conference never fails to get him thinking about all the potential ways there are to adopt a smarter growing operation. But over that time he says the legislative and regulatory changes around the right to farm have been at the forefront of PVGA discussions.
“It’s been very challenging on-farm trying to see the future and how growing systems have to adapt.”
But he’s adamant that growers have got to be proud of what they have achieved with little in the way of resources.
“They’ve been exceptional, but it’s frustrating that we have to keep doing it. And future challenges haven’t gone away with the new coalition government.
He believes a more enabling model is needed which drives investment, science and technology allowing the industry to grow in a more efficient way.
“We need to be able to produce more from less, but without all the regulation.”
While he says the government has shown it is intent on a direction to support the rural sector, there are grower concerns around timing and future changes.
“It’s critical to form a relationship and understanding.”
And for Pukekohe growers getting a framework for that to happen between the government, Auckland Council and Waikato Regional Council is key.
“It’s a case of wait and see.”
One win for the PVGA has been the removal of the Auckland regional fuel tax. “It wasn’t chump change,” he says.
“It added to growers’ cost structures so there was a bit of a celebration at the on-farm level when that went.”
But the PVGA is keeping a watching brief on signalled land use classification changes as well as the future of elite soils.
Simon is quickly coming up to speed on the Integrated Catchment Management Plan (ICMP) where Pukekohe growers are represented by immediate past president Kirit Makan, and by Bharat Jivan and Brendan Balle.
Then there are the wider issues of water, climate and access to markets where he believes a more holistic approach should be taken.
“Sometimes the vegetable sector doesn’t get the recognition of the export opportunities there could be,” he says.
And another area where opportunities abound is for youngsters looking at a career in horticulture. He pays tribute to Pukekohe High School’s head of horticulture, Dave Matthews, who spearheaded setting up a gateway programme which enabled two students to compete in the Young Vegetable Grower of the Year Competition this year.
“There are vast and diverse opportunities in horticulture,” he says.
“With energy and enthusiasm, you can do anything.”


Stomp ® Xtra is a selective, broad-spectrum herbicide recommended for use in certain fruit crops and onions.
• Control annual grasses and broadleaf weeds
• Micro-Encapsulation formulation, which virtually eliminates yellow staining
• Reduced weed control can be expected when used under dry soil conditions
• Solvent free (no fumes or unpleasant odours)

To find out more, scan here or call your local

If you wanted to measure the growth of the apple industry in Gisborne, you could shove a yardstick into the back of one of Mark De Costa’s trucks.
Kristine Walsh
After the Rockit™ harvest ended in the first week of March, Mark’s driving team transported 5500 bins of locally grown fruit – each containing more than 5000 of the small, designer apples – to their exclusive packers in Hawke’s Bay.
“At the same time next year we’re expecting to cart around 10,000 bins,” he says. “And predictions are that within a few years, there will be 24,000 bins coming out of the Gisborne district.”
Mark says that’s due to a number of new plantings, combined with existing plantings coming into full production as they reach five or six years old.
He should know: as both a transporter and grower of Rockit apples he has a bird’s-eye view of how the apple industry has in recent years taken root in his home region.
But that growth has not come easy. Like other Gisborne growers of recently planted apple orchards, Mark has had to deal with the Covid-19 pandemic, followed by long periods of unrelenting rain, topped off with a couple of devastating cyclones.
“The last four or five years have been tough, really tough,” he says. “But we’re at the point where, if we can get through a good spring then we have a strong chance of seeing all that hard work pay off.”
Like many local growers, Mark’s entry to the apple industry came via a roundabout route.
Growing up with his two sisters in the small settlement of Patūtahi, just inland of Gisborne, his parents planted a nine-hectare block of navel and Valencia oranges as well
producing maize, supplying the local Wattie’s factory with summer crops like sweetcorn, peas and beans, and running a few sheep and cattle.
That was in the 1960s and by the time Mark was a fiveyear-old in the early seventies, he was jumping on the farm tractor every chance he got.
I always loved being outdoors and farm life. It was clear I was never going to be stuck in an office
“I guess you could say I’ve got diesel in my veins … I’ve always loved working with big machinery,” he says.
“But we all helped out wherever we were needed, whether that be picking oranges in the August school holidays or getting involved with lambing in the spring.
“I always loved being outdoors and farm life. It was clear I was never going to be stuck in an office.”
Mark later headed offshore to see a bit of the world and upon his return home in 1990, his parents sold the then 23-year-old a four-hectare block with a house on it.
10,000
BINS OF FRUIT EXPECTED TO CART IN 2025
24,000
EXPECTED PRODUCTION (BINS) FROM THE GISBORNE DISTRICT WITHIN A FEW YEARS
Five years later they allowed him to buy an adjoining 12.5 hectares and five years after that, at the turn of the new millennium, Mark completed the deal by buying the family home and citrus orchard when his mum and dad were downsizing their property.
Helping to meet industry demand for workers with a combination of scientific knowledge and business sense.
Next year students will begin studying the new Bachelor of Science – Plant and Horticulture Sciences Major programme. It has also revived its Postgraduate Diploma in Horticultural Science, which will help develop industry knowledge further.
Department of Agricultural Sciences Associate Professor Clive Kaiser said the industry was lacking workers with a sound technical background who could solve whatever problems arose.
“They want technically competent people who understand plant anatomy and plant physiology, who can answer questions and solve problems.”
With a focus on production, students would learn the fundamentals of crop production, as well as how to manage different ecological factors, such as pests or weather conditions.
Agricultural Sciences lecturer Dr Pieter-Willem Hendriks said a key aspect of the education was on sustainability.
Students would learn about pest management, water use and fertiliser application to ensure they could work with the future in mind.They also got an inside look into the industry and connected with farmers, going as far as to help solve issues identified while on field trips.
“The way we approach this really speaks to students. We provide field tours, we go see farmers, we take them on tours to understand the industry.”
Prof Kaiser said the most important message to tell the students was to “grow what you can sell, don’t grow what you can grow.”
The industry was after business-savvy workers who could find plants that were both suitable to grow and economically viable.
“They need students who have that, as well as a decent scientific backbone.”
Having students who had studied horticulture as a dedicated major would be hugely beneficial for the industry and would have positive effects in the years to come, he said.
For more information on this degree please email pieter-willem.hendriks@lincoln.ac.nz

The 2024 season ended with one of the best harvests in several years, and an increasing portion of that crop is coming out of Gisborne.
Figures from New Zealand Apples and Pears Inc. show that in 2017, the area of apples and pears planted in the region was just over 198 hectares, two percent of the national crop (which was a total of 9907 hectares).
By last year that had more than doubled to 449 hectares, four percent of the 11,225-hectare national cropping area.
NZ Apples and Pears says that as of 2023, Gisborne had taken over from Central Otago as the third-largest pipfruit-growing region in the country, though it is well behind the big players of Hawke’s Bay (64 percent of total plantings) and Tasman (23 percent).
The increase was due to Gisborne growers investing in IP (intellectual property registered) varieties, with Envy™, and Rockit™ as well as Royal Gala dominating recent plantings.
“This diversification across the regions – from Central Otago in the south to Gisborne in the North – is really beneficial for the industry,” says NZ Apples and Pears chief executive Karen Morrish.
“It prolongs harvest with various fruit ready for picking at different times, and allows each region to have specialty varieties that do well in their specific climates.”
Meanwhile, NZ Apples and Pears says that while the most recent apple season was a good one, at 18.9 million tray carton equivalents the exportable crop was 11 percent lower than estimated due to the lingering impacts of last year’s Cyclone Gabrielle and spring weather conditions.
But while the fruit was smaller than expected across the board, Karen says fruit flavour and storability were among the best the industry has seen in years, thanks to exceptional summer conditions.
“Long hot days, dry conditions and cooler nights produced apples with delicious eating quality and good colour across most varieties,” she says.
“But at many facilities packing finished earlier than expected so it is likely fruit will be in shorter supply.”



Grower Mark De Costa says there’s an art to getting bud thinning right to ensure the Rockit trees produce large numbers of smaller fruit, while the Envy trees respond with fewer, but larger, apples
In those early years as a property owner, Mark and longtime partner Julie Talmage devoted much of their energy to building up the transport and contracting business De Costa Enterprises, while at the same time leasing up to 500 hectares of land – mainly up the East Coast – to grow squash, sweetcorn, maize and seed maize.
But as the years went by his attention turned back to home ground. In 2017–2018 he planted the 12.5-hectare block in Envy™ apples, then bought 6.4 hectares (directly over the road) for his 2022 plantings of Rockit.
So why did a citrus and corn grower like them apples?
“At the time we thought the Envy would grow well here; it had good prospects in the market, and even better for us, there were no licensing costs (though that has now changed),” he says.
“The Rockit was again an up-and-coming variety and we liked that it would be harvested a few weeks earlier than the Envy, so we could manage a smooth flow of labour.
“But most important was that both would be producing within 18 months, so we could count on getting some return on our investment in infrastructure.”
That did happen … and it didn’t.
“We’ve been facing some hugely challenging weather, but for our first Rockit harvest (in 2024) we managed to achieve a 75 percent pack-out, and the Envy gave 85 percent, so that’s a pretty good result that we look forward to improving on going forward.”
Mark believes his survival in trying times is down to the diversity of his operation, and his willingness to try new things
The two apple varieties are sought after at opposing ends of the spectrum – Rockit’s claim to fame being its compact size, while growers can earn a premium for larger individual Envy apples.
And because he still considers himself a newbie in the field of apple growing, Mark is always willing to learn new ways to achieve that.

At a recent T&G sponsored workshop in Nelson, for example, he was interested to see how more southern growers managed their trees.
“The regions are different in that, due to both soil and climate conditions, trees grow a lot faster in Gisborne but the Nelson growers do cut back quite heavily, so maybe we could be a bit braver in our own pruning decisions,” he says.
“My view is that if you get just one idea from an event, then that’s incredibly useful. Other growers are a fantastic resource so we’ll just suck up anything we can learn from them.”
Overall, Mark believes his survival in trying times is down to the diversity of his operation, and his willingness to try new things.
When Eastland Port trialled coastal shipping for squash exports, for example, his crops were on board. When he
heard about the availability of new platforms for apple pickers, he got a couple of those too.
In terms of diversity, he reckons that saved his skin over the last few tough years.
“It allows us to ride both swings and roundabouts, like while our crops up the East Coast got absolutely smashed in the last big cyclone, the citrus just ticked along doing its thing. And when apple trees were struggling with wet feet, the contracting services were in big demand.”
And, of course, Mark De Costa still likes them apples.
“The Envy trees have pretty much matured, so we’ve got high hopes for the next harvest, and with the Rockit coming up to three years’ old the output from those trees too, should be on the up,” he says.
“Things have absolutely been hard but we’re just going to keep talking to people, learning from them, and sharing those learnings with others.
“That’s the fantastic thing about the horticulture industry and it makes us all stronger.”

APTIVIS® fungicide powered by ADEPIDYN® technology
Next generation control of Black Spot and Powdery Mildew in pipfruit


Scan for more information, visit www.syngenta.co.nz or talk to your local distributor.

® APTIVIS and ADEPIDYN are registered trademarks of a Syngenta Group Company. Registered pursuant to the ACVM Act 1997, No. P010024. Always read the label completely before use. © Syngenta 2024. AD230724

Paul Olsen reckons the industry has turned a corner.
After attending the World Potato Congress in Adelaide, Paul Olsen – chair of Potatoes NZ –sees opportunities for potato growers. He shares his congress highlights as the industry prepares to meet at the Potatoes NZ Annual General Meeting in Ashburton on 12 September.
John Gauldie
“Environmental regulations have put a lot of pressure on us in the last few years but hopefully that is changing now,” Paul says from the family farm in Horowhenua. “It is looking more promising with legislation that the government is working on. It does feel like we’ve turned a bit of a corner. Hopefully that sends the right signals to the bigger players in the process sector, which should be good for growers.”
There is every reason to be optimistic about New Zealand’s potato sector, Paul says.
“At the World Potato Congress, we saw that New Zealand was at the top as far as yield goes. We are probably quite lucky when you look at our natural resources – good fertility, land, water, kind growing conditions for the most part. If you look at some of these other countries, the temperatures, they have a lot going against them and that’s reflected in lower yields.”
Nevertheless, he certainly knows how challenging the last few years were for New Zealand growers.
“I don’t know what average looks like anymore. We lost a lot of potatoes with flooding and wet. We had distribution challenges. That led to an artificial demand and prices reflected that. In some instances, prices were probably double what the market would normally be paying. I think at the moment we’re seeing a bit of a market realignment.”
Yields were more favourable this year thanks to a consistent growing season, but economic woes and household pressure on spending are swinging prices the other way.
“It’s definitely character building. Things will change and evolve. There’s opportunity in export markets. There’s still a lot of opportunity in process growing. I think the big process players have a good appetite for that growth.”
Domestic consumption is still there but people are making different choices.
“At the end of the day we still need to eat. Potatoes are a great-value source of energy and nutrition. But whether consumers are buying a finished product or a raw potato is changing.
“I think sometimes as growers we’re not so end-user focused. On the back of my Nuffield Scholarship I’ve tried to really refocus on the consumer end rather than the growing end.
“Talking to growers at the World Potato Congress, a lot of them are really pushing down the low carbohydrate option to meet the expectation of the consumer. Here in New Zealand I think low carb is probably still a small segment but it’s growing.
“I’ve been trying a bit of Colomba which is a low carb variety under the Sunlite brand in conjunction with GroPak. I’ve been doing that for a couple of years.”
As well as low carb varieties, consumers around the world are looking for more convenience. It can be a challenge for growers to develop their packaging, product range and added value products.
“The larger growers can probably get more involved in the value add with their sheer size and scale. There’s been some really successful marketing done by bigger players. It’s a different skill set within those businesses to achieve that. It’s not a traditional grower machinery background, it’s a marketing degree. This is great to see.
POTATOES NZ
154 GROWERS
9266 HECTARES PLANTED IN 2023
$259,158,000 FARMGATE VALUE
Consolidation and collaboration are likely to continue reshaping the sector, he says. Economies of scale will be the focus for some growers, while others might focus on risk diversification through growing other crops, dairy or dry stock (as in Paul’s case).
“We are losing a few growers, but we’re probably growing the same if not more hectares and that’s due to consolidation, and possibly some bigger growers getting bigger. But it’s a dynamic industry and we will still need growers of all sizes and specialties to service the market.”
As the industry consolidates, ensuring career pathways for young growers is critical.
“It was really encouraging to see so many younger people at the World Potato Congress. You can see that they just have that fire and that passion to be in the industry. That was quite refreshing to see.
“But it’s not just the bigger growers. I think we’ve seen some good collaborations with growers pooling together to get an outcome that’s more favourable.” MULCH


In addition to Moonlight for export and processing, Paul grows Agria for local markets and a Colomba low carb variety under the Sunlite brand in cooperation with GroPak
“When we were growing up, we used to have mashed potato sandwiches for breakfast.”
Paul Olsen says the Opiki farm has been in the family since the 1970s. Paul’s uncle Terry Olsen was Potatoes NZ chair from 2005 [part of VegFed at the time] to 2010. After Lincoln University and working on South Island farms, Paul was drawn back to potatoes and into leadership – initially encouraged by the late Ron Gall [then the business manager for potatoes]. “It wasn’t really a question, it was more that this is what’s happening.”
In the following years he completed the Horticulture New Zealand Leadership, Kellogg Rural Leadership Programme and Nuffield Farming Scholarship trajectories. He chaired New Zealand Young Farmers for a number of years. Meanwhile he and his brother Shaun with the wider family developed the family farm from 130 hectares to just over 800 hectares, keeping a product mix of dairy, dry stock and cropping. In 2019 he became a Potatoes NZ board member and has been chair since 2023. Paul is also an elected Councillor on the Horowhenua District Council representing the Miranui Ward.
“I probably haven’t seen it so much in New Zealand in recent years. We need to be supporting programmes that enable those students or younger people to develop that appetite. It’s something that I’m pretty passionate about. I’m really keen on the likes of Young Grower of the Year to celebrate the success in the industry and younger people coming through. Without them we will struggle.”
As the industry consolidates, success might look different than it has in the past, for example an equity partnership or having a stake in a bigger operation.
“Being an agronomist [within a larger-scale organisation] has its own career opportunities – in contrast to a smaller business where you do everything yourself and often probably don’t do everything as well. There’s a lot more opportunity especially in these bigger operations for younger growers to get skin in the game and progress.”
As the industry develops, consolidation and collaboration should extend to industry good organisations too, Paul says.
“Look personally I don’t have an ego about being chairman of a product group if there’s a better way of doing it.”
Nevertheless, potato growers have varying views about industry good body governance.
“You’ve got to remember that we represent growers from someone growing only potatoes, right the way through to those growing ten different crops or more, and probably paying levies to a whole bunch of organisations. We have to be mindful that we’re doing the right thing with that levy dollar and getting the biggest return out of it for producers.
“Certainly there has been duplication across different product groups and different farming systems. There are a number of conversations going on about how we could work more closely with especially the vegetables side of things. The SVS tool is an example of collaboration that worked well.”
That also applies to international collaboration. At the World Potato Congress, Potatoes NZ’s Iain Kirkwood chaired the launch of the International Potato Partnership R&D Forum. The partnership aims to enhance global collaboration across potato research and industry.
“We’re building those alliances so we can share research and innovation that other countries are working on and vice versa. That’s an opportunity and probably we can collaborate more, rather than trying to do everything ourselves.”

James Millward : MetService consultant meteorologist
With big global drivers like the El Niño Southern Oscillation (ENSO) and Indian Ocean Dipole (IOD) looking set to remain in neutral states until at least late spring, we need to look a bit closer to home and what has been influencing our weather maps over recent months, for clues as to what is coming next. Factoring in the poor performance of seasonal modelling over winter is also likely to bear fruit (excuse the pun!) this spring.
So, what does this all mean for New Zealand this spring? Well most importantly, keep an eye on your forecasts routinely! Things are looking volatile, and with competing local influences and less confidence than normal in the seasonal models, keeping up with weather patterns at more predictable time frames (days and weeks, rather than months) will pay dividends. But let’s pick out some of the key insights for the upcoming season…
With seas around the country now much warmer than three months ago, it looks a safe bet that a milder than normal spring is likely to occur. These warm anomalies right across the country are widely supported in the modelling – but are unlikely to tell the full story.
We need to look a bit closer to home and what has been influencing our weather maps over recent months, for clues as to what is coming next
Early spring will deliver a lot of variability, as is typical for the time of year, and September is likely to see temperatures spiking ahead of fast moving cold fronts, then crashing behind. When you factor in the rare Sudden Stratospheric Warming climate driver and colder synoptics, this may well deliver an elevated risk of frosty mornings in September, especially across the South Island, as well as another heavy snow event or two. As we head deeper into spring, and beyond mid-October, expect warmer than normal conditions.

Higher than normal pressures across southern latitudes of New Zealand have limited the number of Southern Ocean systems affecting the country this winter, with widespread drier than normal conditions across wide swathes of central and western New Zealand as a result. This high-pressure anomaly may well persist or emerge at times this spring.
Sea surface temperatures around New Zealand have now recovered to near normal, after being notably cooler than normal in late autumn.
The Southern Annular Mode (SAM) has been strongly negative from mid-July, likely tied to a rare and unpredictable Sudden Stratospheric Warming (SSW) event over Antarctica. SSWs can enhance westerly weather patterns across New Zealand, with some very cold outbreaks possible too (as seen in the late July snowstorm across the South Island).
Seasonal models have not been performing well and need to be taken with a pinch of salt over coming months whilst big global climate drivers remain neutral.
A weak La Niña event looks likely to develop this summer, albeit we may not hit the thresholds to officially declare the event. In any case, the atmosphere should begin to tilt towards La Niña by the summer months, when it would typically have its greatest impact on New Zealand weather patterns. In late spring we may start to see the fingerprints of this developing event.

Precipitation: Stormy westerlies emerging this September, but hints of a Chatham High by late spring
The first half of spring is expected to see westerly weather take hold, with seasonal modelling predicting significant low-pressure anomalies across the southern Tasman Sea, these extending across New Zealand during September (see Graphic 3 ).
Things are looking volatile, so... keeping up with weather patterns at more predictable time frames will pay dividends
Above/below average Significant
Table 1 : Raw European Centre for Medium-Range Weather Forecasts (ECMWF) monthly minimum temperature anomaly (°Celsius, deviation from 1993 to 2016 average). Forecast anomalies within +/- 0.3°C of the monthly average are considered ‘near average’. Predicted monthly temperature anomalies +/0.3–0.8°C are considered ‘above/below average’, while monthly temperature anomalies exceeding +/- 0.8°C are considered significant (well above or well below average). As a guide, record warm monthly anomalies are typically around 2.0°C – 2.2°C
This is likely to bring much more frequent frontal activity than in recent months, and crucially more of these are likely to originate in the Southern Ocean. This will switch the focus of the wettest conditions to windward western areas (unlike winter), but given the ferocity of the stormy signal, eastern areas of the South Island are likely to see a number of spillover events, with rainfall across the Divide and driving slightly wetter than normal conditions in places like Central Otago, the Canterbury foothills and Marlborough in early spring (see Graphic 2 ). Hawke’s Bay may well see nearer normal rainfall overall, with the eastern North Island generally more sheltered in this dominant westerly flow.
Note that these weather patterns are conducive to some very windy spells of weather, especially across eastern New Zealand, and it is shaping up to be a notably windy start to spring


As we head through October, expect the southern highpressure bias that we saw through winter to rear its head at times, generally settling things down as compared with early spring, and some drier anomalies may well start to develop across eastern and central regions, and the potential for soils to begin readily drying out with strong, warm foehn winds a regular visitor.
In November, these drier regions could become increasingly widespread as a more typical La Niña weather map begins to appear, with higher pressures near the Chatham Islands expected to slowly become the dominant feature into the start of the summer months. This would tend to direct warmer north-east flows across New Zealand, limiting rainfall returns across the lower half of the South Island.


Note that MetService forecasters expect that September anomalies will be cooler than shown here, especially further south.






Graphic 2 (above): Raw ECMWF forecast monthly rainfall anomaly (mm deviation from 1993 to 2016 normal). Green shades indicate wetter than normal conditions, and orange shades drier than normal. Dotted blue lines show major state highways
Graphic 3 (below): Monthly ECMWF forecast monthly Mean Sea Level Pressure (MSLP) anomaly (hPa deviation from 1993 to 2016 normal). Cyan shades indicate lower than normal pressures, and pink shades higher than normal pressures
While the North Island is modelled to be widely dry in November, caution is advised for Northland, Bay of Plenty, Gisborne and the Hawke’s Bay, which can quite frequently pick up heavy rain events in this wind direction. Much will ultimately depend on the strength and speed of our burgeoning weak La Niña and the northern reach of that famous Chatham High pressure cell.
As always, you should keep up to date with the MetService long-range forecast at http://metservice.com/rural/monthlyoutlook, or ask us questions on the MetService Facebook or Twitter feeds.

Horticulture New Zealand has announced 19 new scholars who will benefit from its 2024 Leadership Programme.
NZGrower & Orchardist staff
The successful candidates come from diverse roles ranging from self-employed growers to those working in sales and marketing, export management, human resources and logistics for grower businesses.
They also bring varied experience, ranging from science or engineering backgrounds to previous careers in the army, agronomy, geology, rural banking, auditing and butchery before moving into horticulture.
“What these applicants all have in common is that they have demonstrated leadership or leadership potential and a willingness to assume responsibility in grower or industry matters,” says Nadine Tunley, chief executive of HortNZ.
“The programme is designed for potential and current leaders in the fruit and vegetable industry. They will join the ranks of more than three hundred graduates since 2002 who have developed their leadership knowledge and skills
in a popular and highly respected programme that is well supported by industry leaders.
“The scholarship programme is important to the sector as it continues to grow, with ambitious goals that include doubling the farmgate value of production.
“More than ever, we need a strong pool of high performing leaders that have the confidence and skills to take our industry into the future. This programme will help prepare participants to successfully capture the opportunities and address the challenges that this growth offers.”
This year’s intake of 19 scholars is larger than the usual twelve, says Nadine.
“This was made possible with support from the Grower Relief Fund and the generosity of people who donated to it through the North Island weather events of 2023.


In August, this year’s intake of 19 scholars took part in phase one of the Leadership Programme in Auckland
“We wanted to support businesses affected by the cyclone, so that they could participate in this important programme and look positively towards the future after a challenging few years.”
HortNZ has partnered with New Zealand Rural Leadership Trust (known as Rural Leaders, the trust also provides the Kellogg Rural Leadership Programme) to deliver the renewed programme.

The programme has been reviewed against the current industry landscape and the food and fibre sector leadership framework funded by the Food & Fibre Centre of Vocational Excellence (FFCoVE) in collaboration with Rural Leaders.
“A sustained flow of capable and self-aware leaders is critical to the Food and Fibre sector remaining vital and vibrant into the future. The sector needs leaders that are continuously developing themselves and the teams they work with”, said Lisa Rogers, chief executive, Rural Leaders.


Amy Willoughby
Business development manager forTrevelyan’s Pack and Cool Limited in Te Puke
Annabelle McGuire
Asia sales manager for Kiwi Crunch in Twyford, near Hastings
Bobby Lowe
Commercial manager
SKL Produce, Auckland
Mei Qi Cheah
Post-harvest supervisor for Oakley’s Premium Fresh Vegetables in Southbridge, Canterbury
Jake Tully
Shipping and operations associate for Taylor Corp, Hawke’s Bay
Jeremy Whitten
Operations manager –covered crops for T&G Fresh, from Waiuku
Justin Wehner
Orchard operations manager for Echodale Marketing in the Tasman region
Michaela Horcinova
People and culture partner for Southern Cross Horticulture (SCH) in Tauranga
Nicole Hope
Assistant manager at Craigmore Sustainables’ Springhill Orchard in Central Hawke’s Bay
Niel Redelinghuys
Operations manager, LeaderBrand, Canterbury
Oliver Hoare
Grower services representative for Hume Pack-N-Cool, Katikati
Reuben Carter
Crop manager for Oakley’s Premium Fresh Vegetables in Southbridge, Canterbury
Rowan Wallace
Owner and manager of Zebor Orchard, Tauranga
Sammy Sinclair
Regional postharvest quality manager for T&G Fresh for the Hawke’s Bay/ Tairāwhiti region
Scott Harvey
Onion crop programme manager for A S Wilcox & Sons in Pukekohe
Sinnead Flannery
Horticultural manager for Howatson Rural in Tairāwhiti region
Taurion Colquhoun
Growing supervisor for Kaipaki
Berries in Ōhaupō, Waikato
Tim Officer
Orchard manager of the Dunstan Hills stone fruit orchard in Earnscleugh, Central Otago
Tim Tietjen
Fifth-generation horticulturalist, and orchard owner/manager, Gisborne
EXTRA SECTION FOR YOUR SECTOR
Contents
26 Fight against Stemphylium
28 Vegetables New Zealand: Industry contributions recognised at AGM
30 Potatoes New Zealand: Enhancing agricultural innovation latest R&D
34 Tomatoes NZ: Concern over virus found in Australia
36 Process vegetables NZ: Crop-specific research key for process vegetables
38 SVS Tool available for growers

Fungicide resistance management will be key to winning the fight against Stemphylium. For Onions NZ, DANIEL SUTTON, Vegetables NZ research, development & extension manager, shares preliminary results on new survey work underway with Plant & Food Research and several crop protection companies. As onion growers start a new season, the strategies around controlling Stemphylium leaf blight (Stemphylium vesicarium) will need some consideration. Stemphylium leaf blight is a foliar disease that New Zealand onion growers have combatted for several years. Different regions experience varying disease levels in different seasons, but this is a constant in all onion growing areas. In bad seasons, losses to onion crops can be considerable. Because of this, Onions NZ is continuing to help support growers in the management of Stemphylium through an integrated disease management approach.
Cultural practices are being evaluated for the role they could play in maintaining healthy plants and minimising disease development. Managing water stress, correct nutrition, and reducing physical damage all help to ensure onion plants’ resilience to disease infection. Managing other pests and diseases such as onion thrips and downy mildew also helps reduce secondary infection of Stemphylium. The best way to control Stemphylium leaf blight is to stop its initial infection into the crop.
Figure 1 : Two Stemphylium isolates under evaluation on fungicideamended agar. Growth on the right indicates signs of fungicide resistance. Credit Peter Wright
Fungicides also play a role in preventing and managing the infection of Stemphylium. However, grower feedback from the previous season indicated they were not seeing the expected level of control from several fungicide products. To investigate this, Onions NZ and Plant & Food Research conducted fungicide sensitivity screening on a small sample of paddocks against the commonly used fungicide options. The results of this work were concerning, but due to the small sample area, a true gauge of the situation was not possible.
Resistance was found, especially in the fungicide groups SDHI (succinate dehydrogenase inhibitors, Group 7), QoI (quinone outside inhibitors, Group 11), and DMI (demethylation inhibitors, Group 3).
Resistance was detected across all growing regions. Control options for Stemphylium are limited. Strong resistance management strategies will be required to protect the remaining fungicide activity.
For a better representation of fungicide sensitivity across the country, Onions NZ sampled a larger number of paddocks and assessed more fungicide options. Samples were collected from Pukekohe, Matamata, Hawke’s Bay, Manawatū and Canterbury; and 14 different fungicides from seven different mode of action groups were tested. To help achieve this, Onions NZ asked for and received financial support from several crop protection companies and distributors. Onions NZ would like to thank the following businesses, as without their support this project would not be possible: Adria Crop Protection Solutions NZ, Agrisource, Arxada NZ, BASF, Bayer, Fruitfed Supplies, Horticentre Charitable Trust, Nufarm NZ, Seed & Field NZ and Syngenta NZ.

Figure 2 : Two Stemphylium isolates under evaluation on fungicideamended agar. Growth on the right indicates signs of fungicide resistance. Credit Peter Wright
At the time of writing this article the full results and the report are not available, however, preliminary results make for some grim reading:
• Resistance was found, especially in the fungicide groups SDHI (succinate dehydrogenase inhibitors, Group 7), QoI (quinone outside inhibitors, Group 11), and DMI (demethylation inhibitors, Group 3).
• Resistance was detected across all growing regions.
• Control options for Stemphylium are limited.
• Strong resistance management strategies will be required to protect the remaining fungicide activity.


These results are still being evaluated and resistance management strategies are being developed. Onions NZ would like to acknowledge and thank Plant & Food Research, especially Peter Wright for the work and for his efforts above and beyond expectation to complete the testing from this large survey.
Feedback from the previous season indicated they were not seeing the expected level of control from several fungicide products
On Wednesday 23 October, Onions NZ will be hosting an Annual General Meeting in Pukekohe. This will include a workshop where these resistance management strategies will be communicated to attendees, and additional resources will be distributed for managing Stemphylium leaf blight. Following this event, Onions NZ will work with growers all over the country to help implement these strategies into crop protection programmes. We will also be looking to work with all advisors who provide crop protection recommendations for onion crops to help communicate these strategies and answer any questions about their interpretation or implementation.
If you are part of the industry and want to make sure you are involved in these discussions, please contact: Daniel Sutton : 027 473 2381 daniel.sutton@freshvegetables.co.nz or Kazi Talaska at Onions NZ : 027 211 0507 kazi.talaska@onionsnz.com











Five vegetable industry stalwarts were recognised at the 2024 Vegetables NZ Annual General Meeting (AGM), held in Pukekohe on 8 August.
Antony Heywood : Vegetables NZ general manager
Life Membership was awarded to Geoff Lewis and Mark O’Connor.
Geoff is an asparagus industry and Recognised Seasonal Employer (RSE) scheme pioneer, with a passion for people as well as for growing. He is also a proponent of sustainable family businesses, and has continued to adapt and expand Lewis Farms, which today grows strawberries under cover in addition to asparagus.
Geoff’s willingness to collaborate and share speaks volumes about him both as a professional and personally.
Mark is a man of few words that are carefully chosen. He is to the point and says it how he sees it. When he was on the Vegetables NZ Board, Mark’s favourite question was ‘what’s a grower going to say?’
Mark is the managing director and a shareholder in the Nelson-based family market gardening business Appleby Fresh Ltd. He is on the board of directors for Waimea Irrigators Ltd, and was very vocal in helping get the dam over the line.
Two growers – Lex Dillon and Graham Walker –received Industry Service Awards.
Lex has been actively involved in the horticulture industry for more than 40 years. He has held a variety of roles with the NZ Hothouse group of companies, was a member of the TomatoesNZ Board for almost 20 years, and was made a Life Member of Horticulture New Zealand in 2021.

Mark O’Connor was also awarded Life Membership
Recently, Lex has been involved in the A Lighter Touch and TomatoesNZ project that is investigating and trialling biological control systems in greenhouses.
Graham is a Senior Plant & Food Research scientist, who has considerable expertise in disease and pest management in New Zealand and overseas.
Graham has played a leading role in developing integrated pest management programmes in outdoor vegetable crops, including lettuce and brassica. His experience overseas has been invaluable in New Zealand’s response to Fall Armyworm. It gave the industry a strong starting point with respect to the identification, lifecycle and biological control of this pest.
One grower – Doug Nilsson – received an Industry Merit Award.
Doug is the ultimate kūmara industry team player. After Cyclone Gabrielle when 99 percent of his crop was gone and you would expect him to focus on Dunsmore Gardens, his chief concern was ‘how do we all get through this?’ If you needed someone to talk to, Doug had cold ones in the fridge. If you couldn’t get workers, Doug was ready to get a van full of his on the way. If your power-harrow had broken down, Doug had one you could borrow, and his mechanic would get on to yours as soon as he could.
It’s fair to say that Doug is the driving force behind the recovery that is the kūmara industry today.
Emma Lees has joined the Vegetables NZ Board following the 2024 director elections. Emma is A S Wilcox & Sons’ general manager of people & culture, and has previously been a HortNZ Board Future Director. She replaces Kiran Hari, who did not stand for re-election.

Kiran will however, remain a member of the vegetables.co.nz committee.
John Murphy and Warwick Simpson were re-elected. They both retired by rotation and stood for re-election.
Jasmine Franklin is Vegetables NZ’s new Future Director. She replaces Bobby Lowe, who recently took up the role of secretary with the Dominion Federation of New Zealand Chinese Commercial Growers.
At the Board meeting held directly after the AGM, Warwick Simpson was elected by the Board as deputy chair, replacing Allen Lim. John Murphy continues as chair.





Kate Trufitt : Potatoes NZ chief executive
As the horticultural landscape continues to evolve, research and development (R&D) plays a crucial role in driving innovation and efficiency for growers. From advanced crop protection to sustainable farming practices, R&D is at the forefront of addressing the challenges as well as opportunities faced by modern agriculture.
This article highlights Potatoes NZ’s research, development and extension activities. Current actions focus on monitoring and managing environmental impacts of potato production to provide a pathway to increase the area of production, maintain industry profitability and deliver improvements across the value chain.
In New Zealand, the most commonly encountered and important pathogen of potato is Spongospora subterranea f.sp. subterranea, a tuber and soil-borne plasmodiophorid pathogen that causes Powdery Scab on tubers and root disease. There are currently no effective management tools for Powdery Scab.
Two projects have been proposed: one trial at planting (‘Diffuse to confuse’) and the other immediately postharvest (‘Germinate to exterminate’).
Diffuse to confuse
• Manipulation of soil physiochemistry to reduce infection levels at planting.
• A range of materials have been identified that are capable of interfering with zoospore migration (therefore limiting root infection).
These compounds disrupt the signal from the potato roots, which guide the zoospore to their infection site on the root hairs.
Some also have a biocidal effect killing the zoospores before they can reach the roots.
• This is analogous to pheromone disruption techniques used in orchards to disrupt mating of pests (such as codling moth) but has never been applied to a soil environment before.
Germinate to exterminate

• Manipulation of soil physiochemistry to reduce soil pathogen inoculum prior to planting.
• Identification of bioactive compounds that stimulate Powdery Scab resting spores to germinate in the absence of the host.
• Trialling of freeze-dried sterilised potato waste was highly effective at stimulating germination (and had the added benefit of boosting emergence).
• There has been limited testing of these products on a field scale.
Tomato Potato Psyllid / Liberibacter control
Canterbury Potato Liberibacter Initiative (CPLI), is a project created and funded by a committee of Canterbury growers and processors, with in-kind and financial support from Potatoes NZ.
There are currently nine separate projects: three carried out by Plant & Food Research, five by Lincoln University and one by the CPLI committee.
Project 1: Laboratory testing the efficacy of contact insecticides (completed)
Project 2: Systemic resistance (completed)
Project 3: Biological control (completed)
Project 4: Systemic acquired resistance (completed)
Project 5: TPP lure and traps (completed)
Project 6: Calcium propionate (ongoing)
Project 7: Border plantings (ongoing)
Project 8: Liberibacter bioassay (completed)
Project 9: Boxthorn removal (ongoing)
Project 6 – Calcium Propionate is a project investigating the impact of applying calcium propionate (a food preservative) on potato plants either as a powder, seed spray, soil drench or foliar spray to limit Liberibacter and/or Tomato Potato Psyllid. A field trial will be developed for the coming season.
Project 9 – Boxthorn Removal: Boxthorn (Lycium ferocissimum) is a significant invasive species in New Zealand. It has been identified as a major host (including an over-wintering habitat) for the Tomato Potato Psyllid (and associated bacterium). The psyllid transmits a bacterial disease that causes a symptom known as Zebra Chip disease. This insect pest (and associated bacterium) is having a huge financial impact on potato production throughout New Zealand due to the damage it causes to potato crops.
The focus of this project is the removal of the biggest concentration of boxthorn hedge at the north side of the Rakaia River mouth. The removal of the boxthorn infestations is planned for this coming spring. A mulcher will be used, and a regrowth spray programme will have to be determined.
The Potato Tuber Moth (PTM) project is mostly focussed on Pukekohe with its year-round production and variable irrigation.
Conducive warm and humid weather conditions create cracking in the heavy soils, which allows the moths access to the tubers. The moths are developing pesticide resistance, and there are ambient storage sheds which provide the perfect habitat for Potato Tuber Moth to proliferate.
Potatoes NZ established a Potato Tuber Moth management committee to initiate and oversee the following programmes:
• Testing the efficacy of key chemical controls (completed)
• PTM trapping programme (ongoing)
• In-field trials of alternative chemicals (completed)
• Post maturity and spray-off cultural controls (ongoing)
• In-store PTM management control (completed)
• PTM chemical control field trial (completed)
Currently the focus is on creating a summary document about the efficacy of different insecticides in relation to their impact on beneficials for use by interested parties.
Potato Tuber Moth monitoring (trapping programme) has been a great decision-making tool used by growers and agronomists. There are six different areas being monitored, and this will continue over the next season.





Understanding
Managing Potato Tuber Moth in the field following crop maturity will look at resealing the soil using an updated piece of machinery that will mould itself around the side of the ridge to retain soil cover and therefore control moth infestations by maintaining a physical barrier to the tubers. This mould resealing was trialled, however the machine needed to be adapted and retrialled. We also through collaboration, trialled a mould forming tractor attachment option, which appeared to work well. A formal trial would need to be completed.
R&D is at the forefront of addressing the challenges as well as opportunities faced by modern agriculture
Early Blight control
Potatoes NZ has delivered two projects:
• Early Blight literature review
• Early Blight field trail
Currently the Technical Panel suggested looking at the different Group Seven fungicides to see if there is any resistance to Early Blight, which will be done by Plant & Food Research.

Researchers are investigating possible Early Blight resistance to fungicides
The Sustainable Vegetable Systems (SVS) tool has been developed through industry collaboration to guide growers in their nitrogen management and ensure vegetable growing is sustainable.
The next phase of the SVS project is to keep the platform up and running, promoting it to the industry over the next 12 months and encouraging the farming industry to utilise this exceptional and innovative tool. See the full article further on in this magazine and visit www.svstool.co.nz
Common Scab has been identified as a major issue in potato crops in New Zealand, therefore this project will focus on doing a literature review to understand control options for growers.
Potatoes NZ is committed to keeping growers and stakeholders informed about ongoing research, development, and extension activities. These updates are vital for ensuring everyone in the industry has access to the latest advancements in crop improvement, disease resistance, pest control and sustainable farming practices to enable the continued growth and resilience of the potato industry.



Upper North Island Alan McKee, Mobile: 021 956 701, Email: alan.mckee@tnseeds.com
East Coast & Manawatu Graeme Jackson, Mobile: 021 396 359, Email: graeme.jackson@tnseeds.com
Ohakune & Horowhenua Kathryn Wells, Mobile: 021 475 482, Email: kathryn.wells@tnseeds.com
South Island David Stewart, Mobile: 021 352 764, Email: david.stewart@tnseeds.com
Auckland/Protected Cropping Ingrid Ennis, Mobile: 021 435 493, Email: ingrid.ennis@tnseeds.com

Dinah Cohen : TomatoesNZ business manager
As some of you will already be aware, Tomato Brown Rugose Fruit Virus (ToBRFV) has been detected at two properties in Australia. The virus is not currently in New Zealand and we would like to keep it that way.
If ToBRFV was to get to New Zealand, it could have dire consequences for our greenhouse tomato and capsicum industry. This is because the virus spreads extremely easily and has such a major impact on production, with reported crop losses of up to 80 percent.
I am working with MPI (the Ministry for Primary Industries) and other industry partners to access the most up-to-date information coming from Australia and will provide more updates as they come to light.
ToBRFV was the topic of the TomatoesNZ mini conference a few weeks ago, so we know that our best defence against this highly destructive virus is to keep it out of New Zealand. The second best defence is having strict hygiene measures in place to try to stop this virus from entering your property if it does arrive in New Zealand.

TOBRFV HAS REPORTED CROP LOSSES OF UP TO 80 PERCENT



TomatoesNZ is advising growers to take the following precautions:
• If you see anything unusual in your plants or crop, please contact MPI (0800 80 99 66) or TomatoesNZ.
• Close access to your greenhouses so that only you and your employees can enter.
• You and your employees should have dedicated clothes and shoes to enter your greenhouse.
• Keep all personal possessions out of the greenhouse.
• No tomatoes (e.g. in packed lunches) to be brought onto the property.
• Thorough hand washing, sanitising and foot baths are all essential.
• Tools (knives etc), machinery (pipe rail trolleys etc) and crates are all items that can harbour viruses. Crates should not enter your greenhouse. Tools and machinery should be sanitised regularly, at least after each row.
• If you have more than one property, movement of employees between sites should stop.
Further resources are available on www.tomatoesnz.co.nz, including a factsheet on ToBRFV with photos to help you identify infected plants. However, please report any changes, even if you’re not sure it looks the same.

Puckered and deformed leaves on a ToBRFV affected plant. Photo from gd.eppo.int
In August 2024, Biosecurity New Zealand placed import restrictions on tomato seed and fresh tomato imports from Australia. Imported seeds for sowing from Australia now require testing for the virus prior to arrival in New Zealand. For more details of Biosecurity New Zealand’s response, visit www.mpi.govt.nz/ biosecurity or follow the QR code.



Redpath Greenhouses and Shadehouses, Manufacturing and suppling the industry for over 35years. Designs to suit your business and growing needs from the very large to very small. Designed, Manufactured, Delivered and installed on your site. Council plans and application work included. All buildings provided with manufacturer’s warranty and our construction crews are based nationwide for efficient and speedy assembly and after-sales service. Check out our website below for the full range of buildings, greenhouse films and fabrics.

Process Vegetables NZ held its Annual General Meeting in Dunsandel in August, highlighting industry research and technology. HELENA O’NEILL talks with chair David Hadfield and business manager Matt Thorn about some of the research underway with process vegetable crops.
Reflecting on his first year in the role of business manager for Process Vegetables NZ, Matt says he takes great satisfaction in seeing better growing conditions, greater yields and better pricing for growers.
“This past year we had a record crop from the processing industry because of the really good growing seasons. Retail customer demand isn’t as strong now, so there will be a little less growing this summer.”
Matt says it was great to have growers at the Annual General Meeting (AGM) wanting to understand how the product group is spending their money on the research that’s underway.

Process Vegetables NZ is participating in the A Lighter Touch programme, a major Sustainable Food & Fibre Futures collaboration of 15 product groups. It includes a major extension programme focused on the implementation of agroecological crop protection through the development of specific extension tools, model farms and focus groups to ensure grower uptake of new crop protection practices and integration into everyday practice.
“A substantial part of our budget is in research for process vegetables, and an important aspect of the programme for us has been the trials undertaken in Canterbury around biological products for peas and beans.”
Matt says further pea and bean trials are planned for Canterbury and Hawke’s Bay, pending cost-benefit analysis.
In his annual report, chairman David Hadfield says that in the past year he has often been asked why Process Vegetables NZ is doing this research with biologicals when there are chemistry-based solutions.
“This is true at present, however, overseas markets are demanding that we stop using, or at least reduce the use of much of the chemistry we have access to. By going down this path we are ensuring that the process vegetable sector will continue to have market access and social licence to produce.”
David hopes two demonstration sites in Canterbury and Hawke’s Bay will help show growers and agronomists the progress that has been made, while also allowing for further testing over the next two years.
“We also have a rhizobia project, now in its fourth year. We’ve found some cold-tolerant rhizobia that will start working earlier in the season.”
Biological nitrogen fixation is the process of converting atmospheric nitrogen to ammonia through the legumerhizobia symbiosis.
Last season’s work focused on some field survey work with crops of two different varieties. The results showed that the pea plant is producing large quantities of stored nitrogen in the range of 235 to 329 kg N ha, with the vine after harvest retaining nitrogen in the range of 172 to 221 kg N ha.
Growers need to think seriously about the value of the nitrogen before selling pea vines off the farm, and consider using that pool of nitrogen to start the next crop, he says.
“We found 120 different strains and tested them in the lab against the commercially available rhizobia. From there we’ve narrowed it down to three [strains], and we’ve coldshocked them to simulate a late frost or snowstorm to see if they would come back and start working again afterwards. Most rhizobia in New Zealand soils don’t get active until about 12 degrees C soil temperature. We’ve got these starting to get active down below 5 degrees C.”
David says these new strains could be beneficial for growers planting early peas in Canterbury in particular, and could extend the season in other regions.
“It means they’re getting nitrogen produced by rhizobia a lot earlier than what is currently available to buy off the shelf or is already in the ground. In most places, there are sufficient rhizobia in the soil but there are a whole lot of different groups of rhizobia and only some of them relate to peas. What you need are pink nodules on the roots.”
The first plot trials are due to take place this summer, along with a literature review of the chemical elements that help nodule production.
Process Vegetables NZ’s main focus is research and biosecurity, David says. The product group does have an additional challenge with its makeup of growers, with many running mixed operations.
“I know there are some growers with a whole lot of processing crops, but in general it’s one paddock on an arable operation and they might have potatoes, onions, or another higher value crop. It can be hard to get them excited about a paddock of peas.
“We’re always open to discussing what the levy is and what we’re doing with it. We would like more discussion on that.”

Key process vegetable growing regions are Gisborne, Hawke’s Bay and Canterbury. Volume in tonnes:
• Talley’s market update (Simon Abel)
• Juice Products update (Kevin Teahen)
• Wattie’s update (Greg Noller)
• A Lighter Touch programme and Vegetable Research & Innovation summary (David Hadfield)
• Cold-tolerant rhizobia and evaluation of biological products (Soonie Chng of Plant & Food Research) and Sustainable Vegetable Systems (Andrew Barber)

Bicolour sweetcorn: Uniform 20cm cob with good tipfill. 80–85 days to maturity. Excellent presentation with good flag and husk cover. A nice easy snap makes Launch the perfect fresh market variety. NZ produced seed. Great disease package. New season seed in good supply. HR: Ps, Rp1-d,g,f,j, IR: Et, MDMV
New clubroot tolerant, warm season harvest addition to our broccoli range. High firm dome. Suits fresh cut or trimmed, easy to peel. Uniform maturity with a high % first cut. Outstanding clubroot tolerance produces clean, strong plants.

New to our pumpkin range Baron is early maturing, averages 3.5–4kg, has a small seed cavity, and vibrant orange flesh. Skin is blemish free. Maturity between Pacific King and Invincible. Long storage.
The Sustainable Vegetable Systems (SVS) Tool was launched in early August after four years of development. HELENA O’NEILL talks with those involved with the project and what this means for growers and horticulture service providers.
The SVS Tool is a nitrogen budgeting tool developed with leading agricultural experts, scientists and industry partners. The project has provided growers with a comprehensive evidence-based decision support tool to optimise their nitrogen management practices.
SVS programme manager Andrew Barber says by utilising this tool, growers can reduce environmental impact, increase efficiency and promote sustainable agricultural practices.
“The SVS Tool integrates nitrogen planning with soil testing, progressively overriding modelled predictions with measured results. The real-time data and personalised guidance will help growers make more informed decisions, ultimately improving performance and reducing environmental impact.”
He stresses that SVS is a nitrogen decision support tool, not a calculator. The tool provides fertiliser decisionmakers with guidance on nitrogen applications by modelling nitrogen flows through complex vegetable crop rotations. These nitrogen flows include soil mineralisation, organic matter decomposition and immobilisation from the previous crops, nitrogen fertiliser, and starting and finishing soil mineral nitrogen levels. Planning requires a model to project into the future, but the SVS Tool can overwrite modelled numbers with measured in-season soil tests that reflect the current season’s actual conditions.
“But that doesn’t apply to me? – Okay, let’s tune this to better reflect your operation. Measured numbers beat
modelled numbers every time. Every grower will typically have a nitrogen fertiliser plan, based on a typical season. Every season has its own nuances. The power of this tool is that as you go through the season, while your model projects into the future, your soil testing is what is happening here and now. And that’s how you adjust your practices. You take your measured number, the soil test, it resets the model, and you make a better-informed nitrogen decision.”
By utilising this tool, growers can reduce environmental impact, increase efficiency and promote sustainable agricultural practices
Potatoes NZ has led the project, recruiting key partners Vegetables Research and Innovation (including Vegetables NZ, Process Vegetables NZ, NZ Buttercup Squash Council, Onions NZ), HortNZ and Plant & Food Research. The Ministry for Primary Industries provided government investment.
The $7.5 million project was delivered on budget, and the tool is free to access for anyone.
“Having now launched it, the next stage is getting it into the hands of growers,” Andrew continues.
Almost all vegetable crops are included in the tool, but there will be some that need further work as they may not have the wealth of
information that others have from prior research.
Andrew expects that the user base of the SVS Tool will be both growers and their trusted advisors, including independent agronomists, fertiliser representatives and researchers. Using the SVS Tool will give users increased confidence and awareness of soil nitrogen testing and nitrogen flows, optimising management decisions such as fertiliser application (quantity and timing) and rotation planning (increasing the utilisation of crop residues).
“For the past 20 years, there has been a fixation on leaching numbers. That fixation has funded an awful lot of lawyers and planners to debate those numbers. Ultimately, what has that meant for the environment?
Absolutely nothing. The only thing that the environment sees are practices.”
Replacing nitrogen leaching numbers with practices – budget and soil nitrogen testing – is key, he says.
“Ultimately, the SVS Project has improved understanding of nitrogen management, enabling growers to improve nutrient use efficiency through the adoption of Good and Best Management Practices built upon years of experience and sound scientific knowledge.”
“Farm Environment Plans (FEPs) are here to stay. I think the vegetable industry has been very proactive through NZGAP (Good Agricultural Practice) and creating FEPs that are practical… The good thing about a FEP is that it is based on a risk assessment. If you have a really low risk then your
Displays patterns of Crop N uptake and soil mineral N content during the current crops growth period. The tool recommends an N application whenever soil N drops to 30kg/ha and aims to leave this much N in the soil when the crop is harvested.

The tool recommends an N application whenever soil N drops to 30kg/ha and aims to leave this much N in the soil when the crop is harvested.
1 : Displays patterns of Crop N uptake and soil mineral N content during the current crops growth period
mitigations are proportionally less than if you were high risk. As the risk increases then the mitigations you need to do also increase.”
Andrew says that there is no recommended number of soil nitrogen tests as each operation and each block of land has different levels of risk, which is why testing needs to be proportional to that risk.
“Rome also wasn’t built in a day, and we are now in a phase of building grower confidence in the SVS Tool.”
David Hadfield, chairman of both the Vegetable Research & Innovation and Process Vegetables NZ boards, also grows peas as part of his arable operation in Lincoln. He agrees that the SVS Tool is also justification for a grower’s FEP.
“You can use it to work out the amount of nitrogen you need to put on, and it’s a tool to justify why you’re using that amount. If you’re using the soil tests you can put those in as well. It gives you the S-curve, the plant’s growth curve, and it tells you when the plant is going to need more nitrogen than what is there, or not need it as soon as you think it does.”
“If the project goes on further as a stage two, we will be looking at other nutrients.”
David says there is still work around the breakdown of organic matter in the soil and how fast it releases the nitrogen back into the system in a usable form.


“Over the last three seasons – peas and beans two seasons in a row, last season carrots – we’ve taken soil samples preplanting, taken the plant through, plant and soil samples at harvest time. All to get the nutrient use of that crop, and the nutrient breakdown of the crop that was grown.”
“We didn’t only do nitrogen, we did a full analysis of that material and a full soil sample analysis. We know of most nutrients, and what those crops use. We have that information now from those three crops. Going forward with SVS we won’t need to go out and do the sampling and so on for those three crops.”
There have been years of research work that we have been able to build upon
The Sustainable Vegetable Systems project began in 2019, arising from the scarcity of data on vegetable nitrogen flows, particularly in crop rotation systems, and a need to support growers. Over three years, nitrogen flows were measured through a selection of representative vegetable crop rotations at Plant & Food Research sites in Lincoln and Hawke’s Bay. This work and the data produced laid the foundation for the SVS Tool.
“A tool like this is built upon the shoulders of an awful lot of prior work. There have been years of research work that we have been able to build upon,” Andrew says.
These experiments were supported regionally across New Zealand with increasing engagement with growers to provide valuable insights into vegetable nitrogen optimisation. The project consolidated data from various sources and stakeholders with key inputs from Plant & Food Research modellers, plant and soil scientists. The SVS model was built to help support growers’ nitrogen use decision-making through scientific knowledge, database decision systems and practical support.
Plant & Food Research programme business manager Miriam Hall says the agency is proud to be a part of the project to help shape the country’s vegetable industry to a sustainable future.


Real-time data analysis: The tool offers real-time nutrient management decision-making support for growers and other fertiliser decision-makers.
Customised support: Based on the data collected, the tool provides tailored guidance for nitrogen applications.
Environmental impact reports: Growers can generate detailed reports on their nitrogen practices, helping them meet sustainability goals and regulatory requirements through their Farm Environment Plans.
User-Friendly Interface: Designed with ease of use in mind, the tool is accessible to all fertiliser decision-makers.
“The SVS Tool is world-leading modelling. Creating databased decision modelling tools from collaboration with a variety of stakeholders is critical to support growers.“
This is a highly collaborative project of key vegetable groups with the aim of developing a decision support tool using an integrated data set based on real-world practices that are robust, trusted and reflect industry practice.
Potatoes New Zealand chief executive Kate Trufitt says the tool represents a significant advancement in our efforts to promote sustainable farming practices.
“By equipping our growers with cutting-edge technology and actionable insights, we are taking a major step towards a more sustainable and resilient agricultural future.”
Growers can sign up to use the first generation SVS Tool at: www.svstool.co.nz






Horticulture New Zealand has launched a campaign to create greater awareness among Kiwis about the dedication, hard work and passion that goes into producing New Zealand-grown fruit and vegetables.
The Taste the Yakka online campaign highlights the challenges that growers face and encourages support for policies that support the sector.
It includes a short video which is available on YouTube, information on the HortNZ website and in the wider media and a competition to win a year’s worth of Wonky Box fruit and vegetable deliveries.
Taste the Yakka is aimed to help all New Zealanders, in towns and cities across the country, to connect with where their horticultural produce comes from.

By raising awareness, HortNZ aims to inspire support for policies that will sustain and strengthen New Zealand’s horticulture industry. People entering the competition sign up to the campaign and pledge their support for the sector.


This is especially important when food plays such a key role in people’s lives, bringing together families and friends.
Taste the Yakka is aimed to help all New Zealanders to connect with where their horticultural produce comes from
HortNZ wants New Zealanders from all walks of life to support our horticulture sector and stand with us in delivering fresh, high-quality produce.
We know Kiwis believe in an honest day’s work and getting on with it. That’s exactly what you, our growers are doing every day, rain, hail or shine. This results in some of the best food on earth.
The video shows the process that our food goes through to get from growers like yourselves to the table, the surprises of weather, the research, planning, science, soil, teams, dedication and the passion.
We know as growers you face a range of challenges including extreme weather events, stringent government regulations, sustainability pressures and rising production costs.
Every day, we see you displaying resilience and resolve to overcome these obstacles so you can continue to produce nutritious fruit and vegetables for Kiwi dinner tables.
However, not everyone knows about all these ongoing challenges facing New Zealand food producers.
This campaign exists to change that by fostering a deeper understanding and support for those who work tirelessly to bring fresh produce to our tables.
We want New Zealand to join us on this journey. It is about understanding and appreciating the immense effort, skills, resilience, passion and innovation that go into growing our food.
Recognising the dedication of our growers is crucial for making informed decisions that benefit our food supply, environment and communities. We are encouraging Kiwi consumers to join us in supporting the heart of our nation’s food supply.
For more on Taste the Yakka, go to www.hortnz.co.nz

Contributing writer ELAINE FISHER is retiring after decades of service to horticulture, including stints as editor of the New Zealand Kiwifruit Journal and president of the New Zealand Guild of Agricultural Journalists and Communicators. In her final article for Horticulture New Zealand’s magazines, she reflects on a changing media landscape and half a century of journalism.
Newspapers were arm-stretching broadsheets, and the Saturday New Zealand Herald was door-stop heavy. A plethora of weeklies and magazines served rural communities. Deadlines were daily and radio and television provided the ‘breaking news’.
That was the media landscape when I became a journalist. No computers, internet, cell phones or digital cameras –I remember the nose-stinging smell of darkroom chemicals and the noise and heat of Linotype machines with their crucibles of melting lead.
Unsurprisingly, 50 years on the media has changed significantly. Newspapers have shrunk to tabloid size; many weeklies and magazines have disappeared, and news is ‘instant’ whenever and wherever you want it.
Throughout my career, the basic principles I learnt from tough sub-editors in the Waikato Times newsroom, served
me well. Research, talk to both sides and ask who, what, where, when, how and why, then check your facts. Keep your opinions out of the story, unless it is an editorial. Let readers form their own views.
Failure to do so resulted in a very public summons across the newsroom floor to the sub’s desk for a ‘please explain’. No better way to learn.
Now more than ever, those skills are needed to not only serve the public, but also to protect the craft and integrity of journalism and even democracy.
What is now called The Legacy media – print, radio and television – has suffered and, in some cases, collapsed from the emergence of ‘new media’ – social media, email, search engines and most recently generative AI (artificial intelligence).

broke
The changes began 20 years ago when Facebook launched. People no longer had to rely on the news and views provided by big (or even small) formal media organisations – they had their own voice and the voices of others around the world.
Anyone could be a reporter, quickly uploading information and images based on their own opinions and observations with no critical oversight. It was exciting and liberating but also dangerous on a personal and political level.
The popularity of social media pulled in the advertising dollars of companies keen to tap into new audiences. This hit print media hard, as did significant increases in printing and postal charges.
Rising costs have led to staff cuts, so increasingly generative AI is used to help create news content, including by the NZ Herald which, in July this year, used an AI tool to produce a Weekend Herald editorial about the All Blacks.
According to a 31 July item by Hayden Donnell of RNZ Midweek Mediawatch, New Zealand Herald’s publisher NZME said it should have employed more “journalistic rigour” before publishing the editorial.
Artificial intelligence may be a useful tool to quickly research and assemble information in an overstretched, under resourced newsroom, but not to write an editorial which should showcase the best of human generated writing, style and content.
Following the fallout from the admission by NZME, it’s likely it and other media will disclose the use of generative
AI in future articles. That could be both reassuring and worrying for readers, many of whom already distrust mainstream media and are even more nervous about AI. And with justification. It’s hard to know exactly who is controlling the AI tools, but one thing is certain – every time we use them, artificial intelligence is learning from us and getting smarter.
Print, radio and television has suffered and, in some cases, collapsed from the emergence of ‘new media’
I believe it is time to return to the best principles of journalism: truthfulness, accuracy, objectivity, impartiality, fairness and public accountability. Doing so will help regain public trust and ensure the survival of journalism as a critical part of democracy, to hold power to account and to accurately inform and entertain readers.
One organisation which seeks to help rural journalists do that is the New Zealand Guild of Agricultural Journalists and Communicators. Among its aims are to: “Maintain a high standard of agricultural journalism”, and “Promote better understanding of agriculture, and its place in New Zealand’s economic and social life”.
For decades I have been a guild member and served on its executive and a term as president. The guild has a code of ethics, offers personal development opportunities, seminars and rewards excellence through its annual journalism and communicator of the year awards. Long may it continue to do so.


Technology is of course not all bad. Computers, digital cameras, cell phones and the internet enable me to work from home now, and did so while our children were young, long before Covid-19 made it necessary.
Technology has brought changes unimaginable when I began writing for the Lower North Weekly News in Wellsford in my last year at high school. That opportunity came on the recommendation of the best careers adviser I could have – retired journalist and my school bus driver Gus Dallas.
My first job, straight from school, was with the Plateau Gazette in Taumarunui in 1969. In the years that followed I worked for daily and community papers in Taupo, Hamilton, Whakatane and Tauranga.
It wasn’t until the 1990s that I specialised in horticultural reporting as editor of the New Zealand Kiwifruit Journal. Growers, postharvest operators, scientists and industry leaders patiently taught me about growing, packing and marketing kiwifruit.
I wrote about the launch of Hort16A, the first commercial gold kiwifruit with its distinctive ‘beak’ which taught the industry to handle fruit gently. I also reported on the structural changes within the industry and the branding process which resulted in the Zespri name. It’s amusing now to remember the public uproar ‘renaming kiwifruit’ caused.
I left the NZ Kiwifruit Journal in 1998 to join the Katikati Advertiser, and in 2008, became the Bay of Plenty Times rural editor, including editing the monthly publication Country News. I broke the story about the discovery of the vine disease Psa on a Te Puke kiwifruit orchard on 5 November 2010.
Over the coming months and years, I witnessed and wrote about the pain, sorrow, loss and also the determination and innovation of growers and the industry to survive the impacts of the disease. The threat
was met head on, and the industry survived by working together, being flexible and innovative and never forgetting the human toll it was taking.
I accompanied a group of growers to Italy in 2011 to see the devastation the disease had caused there and to find answers, if any, to combat it in New Zealand.
In 2012 I joined Tauranga based Sun Media, owned by Claire and Brian Rogers, as editor of Coast and Country News. In 2018 I left to write the book Seeds of Success – The stories of New Zealand’s Kiwifruit Pioneers to mark the 25th anniversary of New Zealand Kiwifruit Growers Inc.
It’s amusing now to remember the public uproar ‘renaming kiwifruit’ caused
Together with journalist Sue Hoffart, I wrote for the 2021 publication Psa, The New Zealand Story, produced by Kiwifruit Vine Health and edited by Lisa Gibbison. For some years I have also been a freelance writer for HortNZ’s publications and for the New Zealand Dairy Exporter
Every day as a journalist I’ve learnt something new. It’s a richly rewarding career which has taken me to North America, Italy, Europe, Japan and throughout New Zealand. I’ve been privileged to meet and talk with people from all walks of life and been humbled by their trust, especially those recounting stories of grief, loss and hardship.
I’ve been impressed too, by the generosity of so many who have shared their knowledge, especially those in the horticultural industry.
Now that Graham and I have moved to Māpua in the Tasman Region, it’s time to enjoy family, friends and exploring the South Island and beyond.


Two proposed regulations could change how New Zealand manages gene technology in fruit and vegetable cultivation and food safety.
NZGrower & Orchardist staff
In the last months, further details on gene technology proposals were released by the Ministry of Business, Innovation & Employment (MBIE) and Food Standards Australia New Zealand (FSANZ). This article summarises information produced by government officials to explain proposed changes to regulations.
In August the New Zealand government revealed more details about its proposed Gene Technology Bill, which would establish a regulator to enable New Zealand to safely benefit from gene technologies.
The legislation will be closely based on Australia’s Gene Technology Act 2000, and like Australia, New Zealand will take a ‘hybrid approach’ to regulation, with applications
assessed under a risk framework. This means the government will regulate higher risk activities and exclude some low-risk activities.
Non-regulated technologies and organisms will include some “gene editing” techniques. Applications that would be exempt include those producing results indistinguishable from those achieved using traditional processes or natural mutations – two examples that have been provided are GABA tomatoes (containing gammaaminobutyric acid which can lower blood pressure and relieve stress) and disease-resistant potatoes.
Some technologies and organisms will also be exempt if they are already exempt from current GMO (genetically modified organism) regulations.
For non-exempted technologies and organisms, the legislation will distinguish between contained activities (e.g. undertaken in a laboratory), environmental release, and medical applications.
It is expected that non-exempted crops for environmental release will be assessed for risk on a case-by-case basis. If they are categorised at the highest level of risk, then a full risk assessment will be conducted including public consultation. The regulator would only approve the application if they were satisfied the risks could be appropriately managed.
The gene technology regulator can apply conditions to the licence to manage the risks, for example a boundary or a particular distance to be applied to the perimeter of the crop (similar to conditions currently imposed on use of agrichemical sprays).
The government proposes that any industry programmes that provide suitable assurance will not be overseen or regulated by the gene technology regulator.
Expedited assessments would apply to activities approved by overseas gene technology regulators previously recognised by the New Zealand gene technology regulator.
The proposed bill will also remove the Resource Management Act (RMA) provision that allows councils to restrict use of GMOs.
It is expected that non-exempted crops for environmental release will be assessed for risk on a case-by-case basis
Horticulture New Zealand, the Kiwifruit Breeding Centre and Zespri are part of an industry reference group. MBIE is seeking advice from industry on trade, market access (global regulations), consumer perceptions, New Zealand branding, competitiveness in the global market, commercial and economic impact. MBIE is also seeking industry views on the efficiency, effectiveness, consistency and practicality of policy options.
Legislation will be introduced to Parliament by the end of the year. MBIE is the lead agency for this work. The regulator would be a new business unit within the Environmental Protection Authority (EPA). Enforcement will primarily be undertaken by the Ministry for Primary Industries (MPI).
FSANZ Proposal P1055
Food Standards Australia New Zealand (FSANZ) recently announced proposed changes to how genetically modified (GM) foods are defined in the Australia New Zealand Food Standards Code.
The effect of the proposed change would be to redefine “genetically modified food” (GM food) as food derived from an organism (or cells of an organism) that contains novel DNA (genetic material) as an outcome of the genetic modification process.
This differs from the current approach where food is considered GM food if it is derived using gene technology, irrespective of the outcome of that process.
FSANZ prepared the proposal following an earlier review which concluded the definitions for ‘food produced using gene technology’ and ‘gene technology’ are no longer fit for purpose because they are unclear and do not reflect the diversity of techniques now in use, or that may emerge in the future.
The FSANZ assessment has concluded that when a food derived using new breeding techniques (NBTs) is equivalent in its characteristics to food derived through conventional breeding, it also presents the same low risk. Because of this low risk, a pre-market safety assessment by FSANZ is not needed, and such food should therefore not be GM food for Code purposes.
This will mean that food from a genome edited organism that does not contain novel DNA in its genome will not be considered GM food and will be exempt from regulations (with some exceptions).
Foods produced in, or imported into, Australia and New Zealand that do meet the new definition of ‘genetically modified food’ and are approved for use will be subject to mandatory GM labelling requirements in the Code. If the food is unpackaged, the information must accompany the food or be displayed with the food.
Proposal P1055 commenced in early 2020, following the completion of FSANZ’s Review of food derived using new breeding techniques. The first call for submissions was released in 2021. Submissions on the second public call for submissions close on 10 September.
Current situation in New Zealand and Australia
Genetically modified vegetables, fruit or meat can be sold now in New Zealand and are already regulated under the Food Safety Act and labelled as GM. Food Standards Australia and New Zealand (FSANZ) sets the standards.
There are currently nine GMO crops approved by FSANZ for use as an ingredient in food sold in New Zealand, including varieties of soy, wheat, potatoes, corn and rice. There are no fresh whole GM fruit or GM vegetables in the food supply in Australia or New Zealand.
The majority of GM foods in Australia and New Zealand are from GM crops grown overseas. Various food ingredients from these crops (e.g. oil, flour, sugar) are used in processed foods, some of which are imported into Australia and New Zealand.
No GM crops have been approved for growing in New Zealand. Since the Hazardous Substances and New Organisms (HSNO) Act came into force for new organisms nearly 30 years ago, only three unconditional releases of GMOs into the environment have been approved. All three approvals were for medical uses.
Some GM crops including canola, cotton and safflower are approved for growing in Australia (by the Office of the Gene Technology Regulator).
THERE ARE CURRENTLY NINE GMO CROPS APPROVED BY FSANZ FOR USE AS AN INGREDIENT IN FOOD SOLD IN NEW ZEALAND, INCLUDING VARIETIES OF SOY, WHEAT, POTATOES, CORN AND RICE.
Earlier this year, the Cavendish banana line QCAV-4, genetically modified for resistance to Panama disease (Fusarium wilt) at the Queensland University of Technology (QUT), became the first whole GM fruit assessed and approved by FSANZ and the first GM banana approved in the world. The Office of the Gene Technology Regulator in Australia also approved a licence for the commercial cultivation of the banana line. It is the first time GM food safety and plant cultivation licensing assessments have been conducted in parallel in Australia. However, QUT has indicated there are no immediate plans to commercialise the GM banana in Australia as Panama disease is currently contained and effectively managed in the domestic industry.

Conventional growers understand that gene technology is prohibited under global organic standards. However, not everybody understands why the organic sector wants to keep gene technology in the lab – and therefore not available for commercial release for conventional growers in New Zealand.
NZGrower & Orchardist staff
Brendan Hoare, GE spokesperson from Organics Aotearoa New Zealand (OANZ), wants to improve dialogue with all growers. OANZ doesn’t see why the government’s proposed Gene Technology Bill should split horticulture into those for and against. What is good for the organic sector might also be good for all New Zealand growers.
“It’s true that outside of organic circles, the organic position is not well understood.”
Brendan has an extensive history in the sector nationally and internationally and was closely involved in the long process towards New Zealand’s landmark Organic Products and Production Act 2023. Currently OANZ resources are focused on seeing the national standard and regulations developed and in place.
Meanwhile, the government is on a mission to introduce new regulations on gene technology. In August, the government unveiled the direction it was taking and the timeline that lead agency the Ministry of Business, Innovation & Employment (MBIE) is working toward.
Acting as OANZ’s spokesperson on gene technology, Brendan says the organisation recognises that the government is delivering on an election promise and welcomes the review of the rules. But he believes the organic sector needs to be part of a proper consultation process. OANZ wants the opportunity to directly engage and participate in the discussions.
OANZ REPORTS THE REVENUE FOR CERTIFIED ORGANIC EXPORTS AT $580 MILLION, INCLUDING $70 MILLION IN APPLES AND $160 MILLION IN KIWIFRUIT.

“Bio” or organic produce is becoming high profile at Fruit Logistica. The NZ$245 billion organic global market is the fastest growing multi-food sector in the world. Photo courtesy of Messe Berlin
“Anyone contributing to New Zealand’s export revenue should be welcomed at the table. Given the level of commercial sensitivity to multiple stakeholders, we expect a close engagement with the government. It’s not difficult for the government to engage with us. We have a national organisation. The New Zealand organic community is very united.”
The organic sector is growing steadily and OANZ reports the revenue for certified organic exports at $580 million, including $70 million in apples and $160 million in kiwifruit.
Brendan says that while organics are a small player within horticulture, New Zealand’s current “non-GMO status” (or at least the 30-year effective ban on GMOs) adds a clear point of difference and brings benefits to, not just organic products, but also to New Zealand’s conventional brand propositions globally.
This is also the main reason that the Tasmanian government has extended its moratorium on commercial release of GMOs until 2029.
“As an innovative, high value and diverse, entrepreneurial sector, there is a lot for us to absorb, consider and consult on,” he says. “What’s happening here is happening in many places around the world and all about at the same time. We’re still digesting it as a global organic community.”
New Zealand is an exporter nation – and that applies to organics too. In fact, Brendan says that New Zealand’s organic production has the largest percentage of exports
in the world – 60 percent of the almost $1 billion that the sector generates. This is why New Zealand is more vulnerable to reputational damage than other countries who already permit gene technology or are moving in that direction.
OANZ highlights the potential for growth in organics as a major contributor to New Zealand’s export revenue.
“The organic global market is the fastest growing multi-food sector in the world as it is valued at over NZ$245 billion annually.”
The United States is the world’s largest market of organic food, accounting for 43 percent of organic food retail sales in the world. European Union countries like Germany and France are another large market, followed by China which is already an approx. NZ$22 billion organic market and rapidly growing, according to FIBL (The Research Institute of Organic Agriculture) & IFOAM (Organics International) statistics and emerging trends 2024.
“I’ve just come back from China,” Brendan says. “New Zealand is the only country in the world with an organic equivalency agreement with China. We have a huge market advantage there. Given the progress on organic regulation and the value in leveraging a non-GMO position right across New Zealand’s primary sector, any regulatory change should continue to protect these national advantages in a competitive world.”
He says New Zealand horticulture’s value chain proposition is focused around truth, trust, authenticity and demonstrability. Whether developing that proposition as an organic or a conventional product, growers bank off the same brand New Zealand promise to consumers in the same markets.
“Any change to the promise is a real risk.”
Brendan believes the horticulture sector has too much to lose by rushing into environmental release of gene technology. The sector needs to first understand the dynamics of its country-of-origin branding and its nonGMO status in a rapidly changing marketplace.
Authenticity includes naturalness as well as communicating New Zealand’s world-leading on-farm sustainable practices as part of the primary sector’s wider story.
“We also have to understand what digital has done and is doing. Particularly with horticulture, trade has become really sophisticated. The customer has never been closer… Buyers want a direct relationship with growers. Buyers are looking for provenance. They are taking that growing experience to the market.
However, technology will change how things are authenticated. Brendan says there is a rapid push toward real time measurement and instant traceability. Markets will demand it. Just like spray drift on crops and pesticide in honey, pollen drift from genetically engineered crops can cross-pollinate with organic crops, potentially leading to genetic contamination. This can lead to them losing their organic status if the test is positive. With isotope and PCR (polymerase chain reaction) testing becoming more prevalent, this could become a major problem for all New Zealand horticulture exports.
The government has not invested in understanding the value of New Zealand’s non-GMO status
OANZ believes more work should be done to carefully evaluate the potential returns from gene technology in agriculture with the potential returns from New Zealand’s non-GMO producer status. The organisation cautions against the expectation that gene technology will bring any quick wins for growers.
“I hear the Minister saying that there will be a market for GMO products. Where is the demand? Show us. What is the case for growers? What’s the actual economic case for scenarios like rapid-flowering apple trees? I don’t know. Producers and consumers would genuinely like to see that.”
He also questions assertions that the regulations will be used to develop environmentally friendly varieties. Looking at the Australian Office of the Gene Technology Regulator,
of the 22 current agricultural commercial licences for Dealings involving an Intentional Release of GMOs into the environment, 16 are for herbicide tolerant varieties.
“I think it’s fast and shallow and I don’t understand the vision forward. I think it’s not respectful to growers. These are people who have invested their whole lives and their livelihoods in these markets.”
Food systems take time to change, but brand reputations can be destroyed overnight.
“The government has not invested in understanding the value of New Zealand’s non-GMO status. Let’s get some real data. Let’s get New Zealand Trade and Enterprise involved to do some rigorous work to find out what’s happening in our markets. Let’s understand what we do well and what we do better than other countries. Let’s listen to our customers before ramrodding new regulations in place.”
PneuTrac combines the advantages of a radial agricultural tyre with the benefits of a track delivering unbeatable performance on both steep slopes and muddy terrain, reducing your downtime to zero in demanding conditions.




The Growing Change project helps growers to navigate the government’s regulations that address the decline in New Zealand’s freshwater quality. The project aims to build capacity and capability within the horticulture sector, and enduring support for growers.

Rowena Bennett Growing Change project manager
Growing Change is a three-year collaborative project between Horticulture New Zealand and the Ministry for the Environment and is entering its final year with a focus to launch a microcredential training programme and complete ongoing catchment projects.
The microcredential training programme is a crucial component and deliverable of the project. This programme is designed to educate growers, horticulture advisors and auditors on managing freshwater risks. Developed in partnership with Muka Tangata, the People, Food and Fibre Workforce Development Council, the microcredential
ensures that the skills standards and learning outcomes are aligned with industry environmental codes of practice. Primary ITO and Fruition Horticulture are also integral to the development of the programme, contributing to the creation of study materials and learner resources.
There are ten Growing Change Catchment Projects, each with its own unique freshwater challenges. The catchment projects support growers through a network of advisors and technical specialists across ten selected regions, in completing the NZGAP EMS (Good Agricultural Practice Environment Management System) Add-on for GAP certified fruit and vegetable growers. The EMS is a tool to assist growers in meeting freshwater farm plan regulatory requirements. Noteworthy successes include the completion of Waimea, Manawatū and Auckland-Waikato Catchment Projects. These efforts have led to a significant increase of growers completing NZGAP Freshwater Farm Plans (FWFP), covering nearly 14,000 hectares of productive horticulture land.

Effective sediment retention pond (silt trap) – Tuakau, Waikato (2024)
Additionally, there has been an average six-fold increase of audit-ready NZGAP FWFPs across these completed regions. Ongoing projects include the Selwyn and Clutha catchments, with final catchment projects launched in Northland, Gisborne, Hawke’s Bay and Bay of Plenty. High levels of grower participation and early adoption within the Growing Change project provides a more complete picture of freshwater risk management practices within the catchment/s and wider industry. It also demonstrates strong support for the NZGAP audit and certification process as an efficient and effective way of meeting freshwater farm plan requirements. Together, this strengthens the case for the EMS and Industry Assurance Programmes as a recognised pathway in achieving freshwater compliance.

Regional extension officer
The Waimea Plains project was completed at the end of July 2024. Project funding covered a suite of technical maps for each property and one-on-one advisor support from Mike Nelson of Fruition Horticulture. Growers saw real value in the support provided to prepare and meet their Freshwater Farm Plan regulatory requirements.

Growing Change grower meeting held in Pukekohe introducing the Auckland-Waikato catchment project (2023)
Of the project, one grower wrote: “Thank you very much for providing the funding to allow us to have (our advisor’s) assistance to create our EMS. My initial look at what was required made me throw up my hands in horror, but Mike soon had me settled down and made the task bearable. He had a really good understanding of what was required.”
The Clutha Mata-Au project is being run in two phases. In both phases, advisor support is being provided by Jason Cochrane and Ayla Meikle of Landpro and independent consultant Alex Huffadine. The first phase closed in July, phase 2 is underway, and the catchment project is scheduled to be completed by April 2025.
The Ballance Agri-Nutrients farm sustainability team in Ashburton are providing advisor support to the dozen registered Selwyn Catchment Project growers. In addition to supporting growers in completing EMS add-ons, the Growing Change Project organises and facilitates workshops for growers focused on freshwater risk management. A workshop introducing Selwyn vegetable growers to the Sustainable Vegetables Systems tool (a tool which assists growers in making nutrient application decisions) is scheduled to take place at Plant and Food Research, Lincoln on 18 September.


Arjune Dahya Regional extension officer
The Auckland-Waikato catchment project provided comprehensive support for growers operating across the Auckland and Waikato regions. With growers already implementing on-farm practices across their operations, utilising the NZGAP EMS Add-on was hassle-free and a positive outcome for growers. The timeframe for this project was extended to accommodate additional growers seeking advisory support.
Growers were given the opportunity to work with Growing Change appointed advisors who specialise in compliance, technical advisory and environmental consultancy. Providing growers with the opportunity to extend their business network with local advisors has bridged gaps in capacity and capability, creating pathways for future services.
Regional meetings and workshops were well attended by growers and stakeholders both in person and online, which focused on various topic discussions with regional councils and industry and the introduction of the vegetable sector’s nutrient management SVS (Sustainable Vegetable Systems) Tool.
The Manawatū catchment project provided extensive support to both commercial fruit and vegetable growers operating across the region. Key growing areas including Ohakune, Rangitikei, Bulls, Palmerston North, Opiki and Levin were supported and experienced increased grower uptake of the NZGAP EMS Add-on, placing growers in a proactive position to meeti regional freshwater farm plan requirements.
Various engagement activities with growers across the region were initiated throughout the duration of the project. Grower site visits by the Growing Change team were beneficial in connecting directly with growers on the ground. Regional meetings and workshops were also held in Ohakune, Opiki and Levin, which were well supported by growers and industry representatives.
The events were in collaboration with Agrilink NZ, NZGAP and Horticulture New Zealand Environmental Policy. The events were well attended by growers and stakeholders engaging in various topics relating to on-farm freshwater management, nutrients and other on-farm activities carried out across various parts of the Manawatū region.
For growers seeking additional support, please contact your Regional Extension Officer:
• Arjune Dahya (Northland, Auckland, Waikato, Gisborne, Hawke’s Bay) Arjune.dahya@hortnz.co.nz
• Nat Bond (Bay of Plenty) Nat.bond@hortnz.co.nz
• Mark Shelly (Tasman, Canterbury, Otago) Mark.shelly@hortnz.co.nz

Public and private investment into science, research and innovation within the primary sector continues at pace as our industry works to maintain competitiveness on the global stage, improve profitability in a challenging environment and gain momentum on sustainability practices.
Tayah Ryan : Lighthouse Horticulture
The global adoption rate of new tools and technologies by growers and farmers is variable and often low, with challenges around complexity, unclear value propositions, up-front investment, and risk.1
Grower-led trials are considered a crucial part of the development and adoption process, offering opportunities to test new technologies and practices in a commercial setting, often at larger scale than what is possible in the initial research phase. It is where the nuts and bolts get ironed out and traction begins. In an ideal world, growerled trials should be considered a shared responsibility between growers, researchers, private sector and industry and invested in as such. This article highlights some considerations for growers.
When faced with countless opportunities, being selective in what you agree to trial is important. It is far better to trial one thing well than try to tackle too much at once and not get anything meaningful out the other end. How much research or testing has been done up to this point?
How confident are we in this technology or practice doing what it is meant to do and returning the desired outcomes? What is the opportunity and risk associated with doing this trial, and can that risk be managed appropriately?
Your industry body may also aid your mission. It is worth asking the question whether additional support is available for you as a trialist – this may be in the form of advice, resource or grants depending on what is being trialled and your specific industry.


4. Make a plan
CREATE A NETWORK OF TRIALISTS THAT SHARE THEIR LEARNINGS
optimising the use of one promising alternative product within a conventional spray programme, rather than attempting a complete system change in one season.
When you have made the call to go ahead, spending some time up front forming a brief project plan can be useful. This does not have to be complex, but outlining a bit about the what, the how and most importantly who will do the work should be a focus. It is fairly common for enthusiasm to wane as operational pressures come on, so building assessments into the season plan is more likely to yield the outcomes you desire.
28th October,2022 4
3. Field trial design
Complicated designs suggested by well-meaning scientists can often put people off trialling anything. There is typically a balance here – grower-led trials need to be practical, achievable with the resources available but also achieve meaningful outcomes. It also assumes, importantly, that we are starting from an existing knowledge base – the grower will be guided by the principles and learnings emerging from the research but will often end up adapting the technology to fit their operation.
Every good trial should have a hypothesis –what do we think or hope will happen? The trial is then designed to test that hypothesis. It is important to be realistic – will cover crops result in significant, measurable changes in soil quality in a single season? It is possible but unlikely – some changes take time and we might be waiting years before we see measurable differences. This is not necessarily an issue but does require a ‘realistic mindset’ and longer-term thinking. We also live and work in a biological system and at the hands of Mother Nature. What works well in a wet season may not be as effective as in a drought. At least a couple of seasons of data and learnings are typically required to form a more complete view of something.
5. Make it visible
Getting everyone on the same page, from the manager to the spray operator to the person pulling weeds, will always lead to better outcomes (and less screw ups!) than a random
trial in the back of a block that no-one knows anything about. The block closest to the office is often a good location. It is also a great way to get staff excited about and interested in what’s happening, particularly if the concepts are challenging or different from what they are used to.
6. Fair and equal test
Biological systems are rarely uniform and crops are no different. The ‘edge effect’ of blocks is a great example. Plant health and productivity, pest and disease pressure, exposure to weather, shelter belts and other factors create inherent variation. Applying one treatment along the edge of a block may be convenient, but it is not a fair and equal test if we compare it to another treatment applied to the rest of a block.
7. Replication
GET EVERYONE ON THE SAME PAGE, FROM THE MANAGER TO THE PERSON PULLING WEEDS
9. Embrace collaboration
Consider closely the ecosystem around the innovation or practice – are other growers trialling the same thing? Creating a network of trialists that share their learnings (and failures) along the way increases the rate of learning and leads to a richer experience for everyone involved. In an ideal world, this would be actively facilitated (e.g. industry field days) but can be developed separately outside of this setting if that’s not an option – either way, the benefits stand true.
10. Record the outcome
Too often, innovative trials are initiated but those involved fail to record the outcome. Outcomes (positive or negative) should incorporate data and results where appropriate and a summary of lessons learned.
Replication is essentially applying the same treatment, randomly, to several different plots so that true statistical differences can be detected between treatments. In its simplest form, it means we are conducting the same test on several areas and seeing if we get the same result. Typically, the smaller the differences you are expecting between treatments, the greater the number of replicates required to achieve significant differences.
For those that have visited research sites with complex patterns of small plots, you might be forgiven to writing this off as too hard, but there are several ways we can incorporate the foundation of replication into our trials. If our risk analysis suggests a low or manageable level with the new tool, then we could test our treatments across multiple blocks (for example, a split block with two treatments, replicated across three different blocks). You could also consider partnering with your neighbour, or other collaboration partner interested in adopting similar things, and run one replicate or block each.
8. Technology and precision ag from a trial perspective
The amount of data and information being captured on an operational basis is ever increasing as we look towards a precision approach to growing. This has the potential to serve us well as an industry as we seek to trial innovative solutions to our unique challenges. It also offers opportunities to increase our observations or data points within trials without the heavy reliance on people resource. The digital crop load scan in Figure 1 is a great example of this in action. This was a grower-led trial in kiwifruit (supported through a Zespri Innovation Project) whereby new products were being trialled in a replicated ‘large plot’ set-up applied with a commercial sprayer. The heat map shows fruit density results – spot the ineffective plots!
1. Voice of the US farmer 2023–24: Farmers seek path to scale sustainably (2024). Mckinsey and Company.
2. Social principles for agricultural extension in facilitating the adoption of new practices. Frank Vanclay. In Changing Land Management.







Vegetable growing in Victoria, Australia is “always changing, always evolving,” says Butler Market Gardens chief executive officer, Rick Butler.
Andrew Bristol : Vegetables NZ communications manager
“I’m a sixth-generation grower and I am making decisions for generations seven and eight,” says Rick.
“Our family has been growing for more than 110 years, and we have been supplying the major supermarkets directly for more than 50 years, every day of the year.
“I bought the business off my parents in 2015 and since then, have developed the Butler Gourmet Pantry brand, packaging herbs in punnets and sleeves.”
Rick showed a bus load of delegates around his herb growing operation – situated near Mornington Peninsula, about 45km south of Melbourne – as part of the Hort Connections conference in early June.
“This site used to be used for growing flowers,” says Rick. “Being so close to Melbourne means our herbs can be with consumers in less than 24 hours from harvest, as we are about 40 minutes away from major distribution centres.”
Rick’s business is big enough – delegates saw acres of basil, mint and thyme being grown predominantly under full cover – to negotiate directly with supermarkets.
“I negotiate a standard price for six months, but within that there can be further negotiation if there’s an issue elsewhere in the supply chain, for example. On a Tuesday I finetune orders, and on a Monday I get paid for the last week’s orders.


Butler Market Gardens negotiates a six month price directly with supermarkets
“I am able to employ people who live close by – most are just ten minutes away. These people like working here because they don’t have far to travel and there’s a real sense of community. Most are from families who immigrated to Australia from Vietnam or Cambodia in the 1980s and ‘90s. My staff turnover is very low, and I do not employ anyone through a third party.”
Rick heats his fully enclosed greenhouses for four to five months of the year, using a biomass boiler burning wood waste from CHEP. “If the plants are too comfortable, shelf life is limited due to shock. As a result, I grow mint more or less outdoors.”
‘Growing’s a lot of bloody fun. That’s what keeps you going.’
As part of the bus trip, delegates visited Peter Schreurs & Sons, also on the Mornington Peninsula.
This 420-acre, predominantly leek and lettuce growing operation was established by Peter Schreurs in 1964. The business directly employs 50 to 60 local people, and enjoys low staff turnover.
“We’ve gone out of our way to eliminate crappy jobs like harvesting leeks in the wet and mud in the field. Our focus is to get the product into the packhouse as soon as possible,” says Mark Schreurs.
“We’ve developed our own leek as well as lettuce harvesting machines. We’re on the fourth iteration of our leek machine, which is operated by one person, however, it is that
person that makes this machine. Their role is to ensure it is functioning properly, but not to drive it, at least in the rows.”
Peter Schreurs & Sons is a great proponent of integrated pest management.
“We encourage life. We don’t discourage it,” says Mark. “We build on the biology and not the chemistry, as once the biology is active, it looks after itself.
“We have divided the farm into 30-acre blocks, surrounded by native plants, which provide shelter as well as homes for the beneficials. If we have a problem in one block, our approach is to leave things to nature and then put the block in a cover crop.
We’ve gone out of our way to eliminate crappy jobs like harvesting leeks in the wet and mud in the field
“On each block, we grow two cash crops a year. For the rest of the time, the block is in a cover crop. Our focus is on sustainability and guardianship – ensuring we leave this land in a better place. Our crops do better by not putting so much onto them. For example, we hardly apply any nitrogen now, relying on cover crops and composting, which we’ve done for 15 years. We also now use less water.”
Mark sums up the family’s philosophy by saying, “Growing’s a lot of fun. That’s what keeps you going.”

For NZGrower & Orchardist, MIKE NICHOLS was shown around the Greengrower plant factory in Hamilton by former Massey University horticulturist Dr Huub Kerckhoffs, Greengrower’s head of research.
Is Greengrower, in Hamilton, the future face of horticulture?
Only time will tell, but the forward-looking innovation of Greengrower chief executive Tom Schuyt is certainly a wake-up call for the New Zealand horticultural industry.
The choice of Hamilton as the growing site is logical as half of the New Zealand population lives north of Taupo. Tom told me he has plans in the future to establish a similar operation near Christchurch, and another in Australia possibly near Sydney.
In 2020 Greengrower approached the Waikato Innovation Park team to build the 6200m2 custom designed facility. It may appear to be a relatively small building, but it is capable of supplying a similar quantity of cut fresh greens as 150 ha of field-grown product due to the 13 layers of crop grown, and critically the fact that the plants receive the optimum growing environment during their life. There is no winter or summer in the vertical farm. In addition (and critically) the crops are grown without using any pesticides,
and the growing system is hydroponic, so the produce at harvest is free from soil, and requires no washing before being packaged for sale. In fact it is so dry that a small amount of sterile water must be sprayed on it at harvest to package it easily.
The 6200m2 custom designed facility is capable of supplying a similar quantity of cut fresh greens as 150 ha of field-grown product
Currently Greengrower produces what is best defined as cut fresh greens, which includes a range of lettuces, spinach, brassicas and herbs. In New Zealand this type of product was pioneered by a Massey University horticultural student, Ashley Berrysmith, who brought the concept
back to New Zealand and established a market (through his company Snap Fresh Foods) for prewashed baby leafy greens using a ‘from seed to plate’ philosophy. For this he was awarded the Ernst & Young NZ Entrepreneur of the Year Award in 2007.
The Greengrower system differs totally from the normal production of cut fresh vegetables, which are conventionally grown in the field or in large plastic greenhouses in soil.
Within the Greengrower plant factory will be three tunnels. Currently one tunnel is in operation, and two others are under construction. Each tunnel contains 13 layers of plants in large cell trays, and the trays are moved steadily from a seeding area to a harvest area over a period of about 28 days.
The seeding is done automatically using a conventional air sower, which places a single seed into each specially developed coir ‘glue plug’ in a high-density cell tray.
These trays are then transferred automatically to the germination chamber, and on emergence to a small growing on area. When the plants are large enough (and just before they start to shade each other), they are robotically transferred plant by plant into similar cell trays, but at a lower plant density at their final spacing.





TRAYS ARE MOVED FROM A SEEDING AREA TO A HARVEST AREA OVER ~28 DAYS

The environment in the tunnels is computer controlled for temperature, CO2 level, humidity, and of course light levels, namely duration, intensity and wavelength. Air speed and humidity are also controlled to avoid tip burn of sensitive plants such as lettuce. Water comes from the Hamilton town supply, and prior to use is treated with ozone to eliminate any pathogens.
The hydroponic nutrients are then added to the water using the classical A and B solutions (water-soluble granular (A) and water-soluble powder (B) plant food that contains nitrogen, calcium, iron and other trace elements). The pH (acidity/alkalinity) of the solution is adjusted with phosphoric acid. There is minimal loss of water from the system, as the only water leaving the factory is within the product, as the water vapour in the air is condensed, and returned to the hydroponic system in the nutrient mixing tank. The recirculating hydroponic solution is treated every cycle by ozone and/or Ultraviolet B light to ensure a pest and disease-free solution.
The CO2 in the air is supplemented, and the relative humidity is controlled.
Field or greenhouse grown cut fresh is harvest by a mower, and must be washed several times to ensure any agrichemicals and soil are removed. It then must be spun dry.
In the case of the Greengrower product as it is grown hydroponically and in a sterile environment where no agrichemicals are used it is not necessary to wash it before packaging. The product therefore has a much longer shelf life.
Of course the technology of Greengrower is of international origin. Much of it comes from Elevate Farms in Ontario, Canada and from Finland. Both countries with extremely cold winters. In fact much of the Canadian technology was developed at the University of Guelph, where I spent a year as a visiting professor in 1971, well before plant factories were a serious development, though all the teaching plants for Plant Science were grown in large rooms under fluorescent lights.
There is of course, a limit to how much cut fresh salad New Zealand can consume, and alternative crops are a little problematical. The key greenhouse crops such as tomato, cucumber and capsicum are more complex to produce. Maybe year-round berryfruit production will be next. (There is already a strawberry plant factory at Foxton (26 Seasons) in converted carpet factory premises). My choice would be cherries, where the huge advantage of being able to control temperature would be a major plus in terms of obtaining possibly as many as three or even four crops per calendar year, simply by controlling the winter dormancy. Modern cherry dwarf rootstocks and training systems would mean that large numbers of trees could be grown in a very small plant factory!
In August a Sustainability Summit hosted by United Fresh, in partnership with the International Fresh Produce Association (IFPA), was marked by thought-provoking discussions, innovative solutions and a shared commitment to advancing sustainability within the fresh fruit and vegetable sector.
A central theme of the standout “Packaging, Global Trends and Innovation” panel discussion was the evolving landscape of packaging materials. The panel brought together Tony Sayle, managing director of Jenkins Freshpac Systems; Rachel Depree, executive officer for sustainability at Zespri International; and Sandy Botterill, head of environmental social governance at Foodstuffs NZ. The session was expertly moderated by Tamara Muruetagoiena, vice president of sustainability at IFPA. One of the key trends discussed was the increasing use of recycled PET (polyethylene terephthalate) referred to as r-PET. Often r-PET has been used to augment the use of virgin PET in packaging.

This material supports a closed-loop system, significantly extending the lifecycle of plastic and mitigating the environmental impact of disposal.
Another innovative solution highlighted was the introduction of palm fibre trays, a type of agro fibre (home compostable, biodegradable and kerbside recyclable). This packaging utilises the empty fruit bunches (EFB), sourced from sustainably managed palm plantations, along with kraft paper (30 percent agro fibre and 70 percent kraft paper).
In New Zealand, as with other countries, some manufacturers still incorporate a thin overlayer of virgin PET in their trays to meet stringent food contact regulations. This approach means that the trays are not made entirely from recycled material, reducing the overall sustainability impact.
Conversation also touched on the impending ban on non-homecompostable fruit labels, set to take effect in July 2025.
A number of European manufacturers have invested in advanced ‘super cleaning’ systems that allow for the production of 100 percent r-PET trays suitable for direct food contact. These systems involve more rigorous decontamination processes that exceed the required standards, making it possible to produce trays that are not only fully recycled but also safe for fresh produce.
The panel underscored the importance of adhering to the principles of Reduce, Reuse and Recycle. These strategies are vital in reducing waste, conserving natural resources and minimising energy consumption.
Moreover, the panel emphasised that the endof-life stage for packaging must be considered in tandem with new packaging developments. Compliance with rapidly changing international standards remains a critical factor in packaging design and implementation.
Zespri International shared insights into their strategic approach to packaging, describing it as their “shop window”, a crucial interface for branding, food safety and ensuring high quality kiwifruit.
Zespri’s sustainable packaging initiatives are driven by global regulatory, customer or shopper expectations, with varying demands across different markets shaping their approach.
The conversation also touched on the New Zealand government’s impending ban on non-home-compostable fruit labels, set to take effect in July 2025. The industry remains optimistic, with ongoing efforts to develop a fully home-compostable label, including adhesive, anticipated to bear fruit by next year.
The nationwide rollout of the Farmlands Horticulture brand shows a renewed focus on horticulture across the co-operative – backing up Farmlands’ vision of being the go-to for everyone connected to our land.
The first piece of a complex puzzle has been to provide increased horticulture support in Hawke’s Bay. Chris Binns, Head of Sales & Strategy – Horticulture at Farmlands, says the Bay is a key region for the co-operative as it signals a refreshed offering for the horticulture sector. “For Farmlands to have a national horticulture presence, we have to be a major player in Hawke’s Bay. That really comes back to Farmlands’ policy of being the go-to for everyone connected to our land. If that’s our mantra, then we’ve got to live and breathe it, and that means being everything for horticulture as well.”
“Horticulture is not just a box to tick; it’s one of the major pieces of New Zealand’s primary industries, so we have to give it renewed support and offer a high level of service nationwide. We do horticulture very well in the Bay of Plenty, and we are having some real growth in places like Northland, but we need to make sure that we are investing in capability right across the country, and Hawke’s Bay is the next big piece of that puzzle.”
To support horticulture in Hawke’s Bay, Farmlands has opened a new dedicated ‘Horticulture Hub’ in Hastings, which Chris says will serve several important functions. “Our growers will be able to come in, they’ll be able to see somebody there. It will be a base for our expanding team of technical advisers, and our supply chain will be smoother as it will also be a distribution centre for agrichemicals and for horticulture. You will still be able to come and pick stuff up, which will be perfect. It will have a sales operation, so it will be a little bit different to a standard distribution centre.”
Chris says with the horticulture sector becoming increasingly sophisticated and tech-focused, Farmlands needs to ensure it has an offering fit for the modern-day grower, and this not only ties in with Farmlands’ new ordering tool FarmlandsPRO, but the new regional hub system the co-operative is implementing in its supply chain to improve efficiency. “There’s a combination of so many things: not only technology changing on-farm, but it’s about how we best support our customers’ needs, in the most cost-effective way.”

Binns, Farmlands Head of Sales and Strategy – Horticulture
“Part of that is operating better from within a hort hub, a regional hub like this, and having our transport and supply chain capabilities in the right place, whether that’s to a grower through us from a supplier, or supplier direct to grower, or importing products from offshore to our regional hubs. The one bit that doesn’t change is our shareholders’


who make the new Farmlands Horticulture brand tick at www.farmlands.co.nz/products_ and_services/horticulture.html
